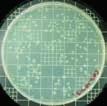

Caring for water and Country awa.asn.au environment | innovation | community | business | technical papers VOL 07 / APRIL 2023
Fully-custom, geared electric motors
With over 75 years’ experience creating the perfect combination of motor and gearbox, Parvalux offers thousands of standard AC, PMDC and BLDC electric motor options, along with a diverse range of inline and right-angle gearboxes.
Our standard products can be easily customised to meet your exact requirements; with options including motor speed, gear ratio and a range of IP ratings, Parvalux products reliably provide the power needed in a myriad of environmental conditions.
www.maxongroup.net.au sales.au@maxongroup.com

Fully-custom AC and DC electric motors
With over 75 years’ experience creating the perfect combination of motor and gearbox, Parvalux offers thousands of standard AC, PMDC and BLDC electric motor options, along with a diverse range of inline and right-angle gearboxes.
Our standard products can be easily customised to meet your exact requirements; with options including motor speed, gear ratio and a range of IP ratings, Parvalux products reliably provide the power needed in a myriad of environmental conditions.

www.maxongroup.net.au
sales.au@maxongroup.com
POWER THROUGH 400 HOURS OF INTENSIVE, FORMAL LEARNING AND PRACTICE IN JUST 3 MONTHS!
Learn faster, learn better, in a real plant.
Simmonds & Bristow has been providing exceptional learner outcomes and qualified operators as an RTO since 1998.


We know first hand that training using real equipment in a real network and/or treatment plant environment gets the most engagement from learners, and yields the best results and retention.
Now, we’ve crafted a training program that will deliver that, faster! Learners will arrive to training daily over a 3 month period just as they would to a real job, working on real equipment, in a real plant.

COURSES OFFERED IN THIS PROGRAM:
NWP30219‑NWP30222
Certificate III in Water Industry Operations (Treatment)
NWP30219‑NWP30222
Certificate III in Water Industry Operations (Network)
To secure a limited place or find out more, email us at help@simmondsbristow.com.au or call us on 1800 620 690 (Only 8 places are available per quarter.) simmondsbristow.com.au
.. . . . . . . . . ...... . . . . . ...... . . . . . . . ...... . . . . . .... RAC E ERREADY IN3MO N SHT
It’s hands-on, it’s practical and it’s POWERFUL!
RTO 1735 ABN 33 010 252 418
32
WATER REFORM JOURNEY
As a surge of water reform is set to drench Australia, Current looks at what’s driving the renewed federal focus and what it might mean for the water community.
32
40 NEXT WAVE
Dr Phil Duncan on the Voice to Parliament referendum
44
COSTING CLIMATE CHANGE
Why resilience is essential to curbing impact
50
RAINFALL RUNOFF RELATIONSHIPS
Understanding catchment rainfall runoff relationships
56
76
92
56 BRIDGING THE GAP
Navigating the skills shortage crisis
64 INTERSECTIONAL DIVERSITY
Q&A with engineer Dr Marlene Kanga
68
PARTNERING FOR INCLUSION
How supporting diversity delivers benefits
76
JUST TRANSITIONS
Addressing inequality during decarbonisation
82
WATER FOR LIFE
Providing water for dialysis on Country

86
INDIGENOUS RESEARCH METHODOLOGIES
First Nations Knowledge for water management

92
DIGITAL GREENING
How is digital technology driving sustainability practices?

98
WATER RECLAMATION

The power of data-driven water engineering
102
GREEN HYDROGEN BOOM
Details on the Hydrogen Energy Supply Chain project
THE OZWATER’23 ISSUE
5 Australian Water Association









Discover more. awa.asn.au AWA OPTIMISATION MODELLING CIRCULAR ECONOMY OPTIONS SUSTAINABLE SYSTEM SERVICES CHLORAMINE TRIALS APPLYING DIGITAL TWIN TECH SECONDARY CLARIFIERS REMOVING POLLUTANTS BUSHFIRE CONTAMINANTS CHLORINE GUIDANCE VALUES OPTIMISING DEMAND PATTERNS STUDENT EDITION 108 111 112 115 116 118 121 123 125 129 130 14 INTRODUCING STRATEGY’25 The Association’s strategy for the next three years 15 NEW BOARD OF DIRECTORS Welcoming our new Board of Directors 16 NATIONAL WATER WEEK The successful 2022 event and what’s planned next 26 MENTORING Lending an ear for career progression 19 OZWATER’23 The premier conference for water professionals 22 WATER AWARDS Recognising outstanding achievements in 2022 THE OZWATER’23 ISSUE 14 16 19 6 Ozwater'23

Current_185x250.indd 2 16/3/2023 8:38 am
EDITORIAL SUBMISSIONS:
Acceptance of editorial submissions is at the discretion of the editors and editorial board.
TECHNICAL PAPERS: Submissions should be 3000–4000 words long and accompanied by relevant graphics, tables and images. To submit a paper or for more detailed submission guidelines, please email journal@awa.asn.au
NEWS AND FEATURES: News tips, submissions and press releases should be sent to cecilia@mahlab.co
COPYRIGHT: Current is subject to copyright and may not be reproduced in any format without the written permission of the Association. Email james@mahlab.co
DISCLAIMER: The Association assumes no responsibility for opinions or statements of fact expressed by contributors or advertisers. Mention of particular brands, products or processes does not constitute an endorsement.

Produced by
369a Darling St, Balmain, Sydney, NSW 2041
Managing Editor
James Chalmers
Editor
Cecilia Harris cecilia@mahlab.co
Creative Director
Gareth Allsopp
Art Director
Sonia Blaskovic
Production Manager
Lisa Galvan
Publishing Director
Jelena Li jelena@mahlab.co
Advertising Manager
Stuart Neish sneish@mahlab.co
CHIEF EXECUTIVE Corinne Cheeseman
Head of Communications and Corporate Services
Kylie Hawker
Email: KHawker@awa.asn.au
Design and Brand Lead
Briony Russell
Email: BRussell@awa.asn.au

Content and Education Lead



Jenny Hiller
Email: JHiller@awa.asn.au
TECHNICAL ADVISORY COMMITTEE:
Dr Robbert van Oorschot (Chair) GHD, Ted Gardner (rtd); Dr Andrew Bath, Water Corporation; Dr Dharma Dharmabalan (rtd) TasWater; Robert Ford (rtd), Central Highlands Water; Dr Lionel Ho, SA Water; Karen Rouse, Water Research Australia (WaterRA); Dr Tim Muster, CSIRO Land and Water; Asoka Jayaratne, Yarra Valley Water; Joe Pera, Water NSW; Kala Senathirajah, Water Corporation; Nick Swain, SA Water; Daniel Visser, GHD. Water e-Journal Coordinator: Kyllie Whitehead Email: journal@awa.asn.au
is the o cial magazine for members of the Australian Water Association. Suite 801, 9 Help Street, Chatswood, Sydney, NSW 2067 | Cammeraygal Country Phone: (02) 9436 0055 Email: news@awa.asn.au
The Australian Water Association acknowledges the Traditional Custodians across Australia, where we live, work and play, for their deep connection to our precious waters and land. We pay our respect to Elders past and present, and the ancestors who have cared, protected and nurtured Country for many thousands of years.







8 Ozwater’23
Can we pump it? Yes we can!




Celebrating 150 years of pump technology, our pump range was developed as a result of our experience working with construction customers around the world.





The rst focus, of course, is providing efficient products. We strive to develop products that are better for you and better for the environment.














































































Secondly, the products should be easy to take to your point of work. Therefore we put a huge amount of focus on making products that are smaller and lighter, with features that make them easy to move.















Scan the QR code for more information
FROM THE CEO
READY FOR CHANGE
There hasn’t been a more exciting time to lead the Association, as we head into an era of significant transformation that will not only affect the health and wellbeing of people and the environment, but also economic prosperity and First Peoples’ connection to Country.
Post-lockdown, we are delighted to reconnect in-person, as we share, connect and inspire. Ozwater’22 saw a record turnout and our State Branches and Specialist Networks have enjoyed renewed in-person opportunities.
The Association continues to support a sustainable water future by: enabling connectivity through our Specialist Networks; contributing to achieving Sustainable Development Goals internationally; promoting diversity and inclusion through participation, engagement and advocacy; and celebrating members’ success through our water awards.
Insights from our All Member Survey in 2022 show that our members value the opportunities the Association provides to gain and share expertise, and strengthen networks. Member feedback has also helped shape Strategy’25 and we look forward to building on our offerings to improve our engagement and communication.
Beginning with the development of our Reconciliation Action Plan, we have improved our understanding of First Nations’ water culture. Our collaboration with WSAA on Voices for the Bush brought together government agencies, utilities, professionals, academics and regional and remote communities to listen, reflect and discuss local issues.
Last year’s National Water Week (NWW) theme, Our Water Stories, saw the Association celebrate its members’ journeys as we engaged with the broader community. Our NWW Ambassador’s program connected ambassadors and schools to inspire the next generation. For National Water Week 2023 (16–22 October), the
theme United by Water will showcase how we connect and collaborate with the broader community for a sustainable water future.
Our International Program saw the return of travel to our partners in Vietnam, Cambodia, Indonesia and the Pacific. We’ve been connecting our members with overseas trade markets, and improving water security in Vietnam and Indonesia. Building on previous successful twinning programs, we commenced our Capability Enhancement Program, designed to accelerate climate smart and resilient water development through partnership and capacity building. We have matched the following six water utilities:
• Vietnam: Can Tho Water Supply and Sewerage Company and Urban Utilities; and Hoa Binh Clean Water Company and Cassowary Coast Regional Council



• Indonesia: PT. Air Minum Giri Menang (Lombok) and TasWater; and Tirta Musi Palembang City and Yarra Valley Water
• The Pacific Islands: Solomon Water and Unitywater; and Tonga Water Board and Goulburn Valley Water
We have also continued to progress and champion sustainable biosolids management, providing a platform to unite utilities, consultants, academics and government through our industry funded Australian and New Zealand Biosolids Partnership. We held the AWA National Biosolids Conference in Sydney with record attendance.
The Association continues to drive prosperity and sustainability for our members by providing individuals with career enrichment and organisations with business opportunities. I’m proud of the commitment our team and volunteers exhibit as they deliver valuable initiatives to engage with and support the needs of our members, and celebrate their successes.
CEO Discover more. awa.asn.au
With the water community set to work through incoming changes, Corinne Cheeseman takes stock of the Association’s recent achievements and reflects on the strength of its members.






 A product development by
A product development by
FROM THE PRESIDENT
STRONGER TOGETHER
Iam writing this column from Quandamooka Country and I would like to acknowledge the Quandamooka People as the Traditional Custodians of the land, and pay my respect to elders, past and present.

Looking back on the last couple of years, it is hard to believe how volatile the world we live in has been. There has been inflation and high interest rates, staff shortages and disrupted supply chains, and continuing extreme events, with much more volatility to come.
Against this backdrop, we have a lot to do to elevate water beyond the sector. We need to increase our discussion of climate impacts, and how the industry is adapting and mitigating them. We need to seize the opportunity presented by the renewed National Water Initiative to reinforce the critical role of water in creating prosperous and liveable places. With so much going on in this sector, it is important to have open and regular opportunities for our members to engage with government, regulators, and each other.
As Australia’s largest water network, the Australian Water Association’s purpose is to inspire and drive a sustainable water future, so that we meet our 10-year aspiration for water to be recognised by all as essential to economic prosperity, health, the environment and Indigenous connection to Country.
Like most of you, I have been informing myself about the Voice to Parliament.

At the Canberra dinner in mid-February, after the Welcome to Country, Aunty Violet
Sheridan shared what the Voice meant to her, and her children and grandchildren. Aunty Violet’s message was moving and impactful, and highlighted what an important time this is for First Nations Peoples and our collective nationhood. I thank Aunty Violet for sharing her story. While we will all cast our individual vote in the upcoming referendum, I also commend Dr Phil Duncan’s contribution to this ongoing discussion on the Voice to Parliament in this edition of Current (Voice for the Future, page 40).
The Association launched its next three-year strategy at our AGM in November 2022. Strategy’25 was developed in collaboration with our branches and staff, and all members had an opportunity to contribute.
The key pillars of our strategy are Member Experience, Water for Sustainable and Resilient Communities, and Indigenous and Community Collaboration. Together with the Board, I look forward to providing updates on our progress as we implement the strategy.
Ozwater’23 marks my last days as President of the Association, and it has been a great privilege to have served in the Association’s 60th year. It has been a highlight to travel again and meet some of you at our events around the nation. Seeing so many passionate and engaged people in our industry makes me feel optimistic for the future.
Today, we have over 300 volunteers on our Board and in our committees. I thank the Association’s volunteers, CEO Corinne Cheeseman, the staff and my Board colleagues for their dedication and support during my term as President. I look forward to seeing you all at Ozwater’23.

President Discover
Set to complete her term as President, Louise Dudley reflects on her time in the role and why coming together is more important than ever.
more. awa.asn.au
PROTECTING OUR MOST VALUABLE RESOURCES

The Hydroflux Group consists of eleven specialist water companies serving the municipal, mining & industrial sectors. Our offerings include design & construct projects, technology supply, aftermarket services and chemicals. www.hydroflux.au 1300 417 697
SHARE, CONNECT, INSPIRE
INTRODUCING STRATEGY’25
Unveiled at the 2022 AWA Annual General Meeting last November, the Australian Water Association’s next three-year strategy is now officially underway.

Building on the successes of Strategy’22, Strategy’25 sets out the Association’s plans and focus areas for the coming years, including a continuation of the Association’s core value proposition: to drive prosperity and sustainability by providing individuals with career enrichment and organisations with business opportunities. The Association will continue to meet this goal by sharing information and knowledge, connecting members with industry and stakeholders, and inspiring positive change.
Developed by the Board, Strategy’25 was created in consultation with the Strategic Advisory Council and the Association’s members and team, and was informed by






an all-member survey. For the first time, AWA’s three-year strategy includes a 10-year aspiration to ensure that water is recognised by all as essential to economic prosperity, health, the environment and Indigenous connection to Country.

Strategy’25 is defined by three focus areas – Member Experience, Water for Sustainable and Resilient Communities, and Indigenous and Community Collaboration – and reflects the development of the Association’s Reconciliation Action Plan. The strategy also outlines the Association’s focus on leveraging People and Culture, as well as Data and Digital, in order to enable progress in its focus areas. To learn more about Strategy’25, visit awa.asn.au/about
FUTURE OF WATER SURVEY
In 2022, the Australian Water Association teamed up with Arup to launch a national survey to better understand Australians’ perspectives on the challenges and issues for sustainable water management.
The Future of Water survey gave all Australians the opportunity to have their say on our water future, with the results set to inform the water sector on what matters most to the communities they serve. The survey captured over 750 responses, providing invaluable insights on how individuals and communities across Australia value and interact with water, and key priorities for future water management at both a local and national level.
Received from a diverse range of geographies, industries and demographics, responses included perspectives on recycled water, climate change, sustainable water management and water habits.


Interested in learning more about the results of the Future of Water survey? Scan the QR code to access the o cial survey portal.

14 Discover more. awa.asn.au Ozwater'23
WELCOMING OUR NEW BOARD OF DIRECTORS
The Strategic Advisory Council (SAC) of the Australian Water Association has elected the Board of Directors for the next two-year term, commencing in May 2023. The directors were ratified at the Annual General Meeting held on 17 November 2022, attended by 76 members.

The SAC appointed nine directors to the Board, including four returning Directors, as well as President Louise Dudley and President-Elect Peter Dennis. The Association is pleased to announce that the Board of Directors will consist of the following after Ozwater’23:
“I would like to congratulate all the successful incoming Board members who will form the new Board in May 2023 under Peter’s leadership as incoming President from that date,” Louise Dudley said. “I would also like to










highlight the vast contribution that outgoing Directors Karlene Maywald and Jim Athanas have made to the Association. I am glad to have served alongside them and thank them for all their work.
“I would also like to thank all candidates who applied for the Board positions. It was such a wealth of talent that made the task of the Strategic Advisory Council extremely difficult to fill the vacancies.”
A round-up of news, upcoming events and key developments in the world of water.
Shelley Shepherd
Daniel Sullivan
Chris Bulloch
Louise Dudley Immediate past-President
Eric Vanweydeveld
Sandra Hall
Kevin Werksman
Clare Porter
15 Australian Water Association Insights
Peter Dennis President
SHARE, CONNECT, INSPIRE



Hosted by the Australian Water Association, National Water Week is held every October to inspire communities and organisations to discuss and learn about water issues, and contemplate how we can use and manage the resources sustainably.

Held from 17-23 October in 2022, last year’s event was themed ‘Our Water Stories’, inviting the community to explore their own stories and imagination through past, present and future lenses. With everyone encouraged to share their water story, the event was more successful than ever at raising the profile of water’s value, and fostering deeper understandings of how we all connect to our most precious resource.
Many of our members held National Water Week events right across Australia, including educational visits from the Association’s Ambassadors, who volunteer to visit local schools to talk about the value of water and help promote the water sector as a rewarding career path.
Becoming an Ambassador offers members the opportunity
to showcase projects, research and innovation, as well as take a leading role in helping to engage the new generation’s interest in the water cycle.
For National Water Week this year (16-22 October 2023), the Association intends to push the profile of water even higher.






















The Ambassador’s Program is set to expand, with the Association encouraging water community members to sign up. The Association will also have a suite of curriculum tools and resources available to help member organisations set up their own community events.
For National Water Week 2023, the Association encourages all members to consider how they will celebrate and take advantage of the platform as an opportunity to raise the profile of water within their community.












Visit nationalwaterweek.org to learn more about how you can get involved in National Water Week this year.
VALE MARK PASCOE

On 13 August 2022, the Australian water community said goodbye to Mark Pascoe, one of the sector’s long-standing leaders, influencers and advocates. Pascoe served the Association as President (1995-97) and as a committed volunteer for more than 30 years.
With a career starting at Brisbane City Council in 1973 and ending in the role of Chief Executive O cer at the International Water Centre, Pascoe is remembered by colleagues and friends for his generous spirit, warming presence and tireless dedication.
AWA past-President Darryl Day said Pascoe was an inspirational leader, mentor and friend to the global water community.

“His vision, strategic intervention and courage changed the policy of governments and aspirations of organisations, but his greatest contribution is the friendship extended to everyone he met,” Day said.
“Mark’s capacity to connect, and support his extensive network, with empathy and friendship is unrivalled.”








16 Discover more.
Ozwater'23
awa.asn.au







Odour Control?
Clean TeQ Aromatrix is at the forefront of environmental air-quality management. Our innovations and technologies are based on more than 30 years of research and experience. Our technology suite comprises biological air treatment systems, activated carbon scrubbers, chemical scrubbers, catalytic iron filters, aeration towers and regenerative thermal oxidisers, together with fibreglass ducting and cover systems.

been operating since August 2022. The Catalytic Iron Filters use ‘rusted’ (Iron Oxide) metal Pall rings which under controlled moisture conditions, reacts with gaseous Hydrogen Sulphide to form Iron (II) Sulphide. The Catalytic Iron Filters achieve a Hydrogen Sulphide reduction efficiency of up to 90%. The Activated Carbon Filters provide the remaining treatment to achieve a design concentration of less than 0.1 ppm Hydrogen Sulphide and less then 500 OU. Recent performance testing has shown inlet odour concentrations up to 360,000 OU being treated to below detection (<30 OU).
We have recently installed a combined Catalytic Iron Filter and Activated Carbon Filter system to treat up to 3,450 ppm of Hydrogen Sulphide gas together with other sulphur and volatile organic compounds. The system was installed for Melbourne Water’s Eastern Treatment Plant and has now

Our extensive experience in the treatment of odour is world class. In conjunction with our partners, we strive to deliver superior outcomes for our clients. From the simplest odour reduction problem, to the most complex emissions for strict environmental compliance. Your problem will be solved!
Come visit our stand M14 at Ozwater’23

Our technologies & services +61




www.clqa.com.au
10 -12 May 2023, ICC Sydney.

7 3711 2694
| info@clqa.com.au
Odour Management Consulting Odour Control Facility
and Maintenance We’ve
Service
got you covered!
It’s been a turbulent few years for the water community. From a global pandemic with local consequences, to the mounting pressures of the cost of living, extreme weather events and the race to net zero – there have been plenty of hurdles to jump, producing new learnings and insights to share.
Reflecting on the theme of Ozwater’23, United by Water, Sydney Water Managing Director and Ozwater’23 Committee Chair Roch Cheroux said this year’s conference is all about honouring the community’s unified dedication to our most precious resource – water.

“Following some really challenging years for everybody, the Ozwater’23 Committee selected this theme to celebrate, not only the fact that we are able to come together to learn from and promote our own industry, but also to acknowledge that water is such a key nexus to so much of what our communities value in Australia and around the world,” he said.
“As such, the various restrictions over the last two years made us appreciate our natural resources even more than we normally would.”
Cheroux said there is a lot happening across the sector to mitigate the impacts of climate change, meet the expectations of growing populations and increased service levels while considering cost-of-living pressures, and this work necessitates a cross-sectoral approach.
“This includes collaboration and partnerships with First Nations representatives and other utilities both domestically and internationally as well as collaborations with other sectors like energy, waste and construction to deliver outcomes more sustainably, efficiently and innovatively,” he said.
“All of us need water, and the services provided by our industry are no small part in what contributes to the quality of life we enjoy here in Australia.”

Australian Water Association 18 Events
Ozwater’23 provides the opportunity for the water community to come together to foster a deeper understanding of the challenges and opportunities that lay ahead, and learn from one another about how to manage them together.
10-12 MAY, SYDNEY


AUSTRALIAN WATER AWARDS
Congratulations to all our 2023 National Water Awards finalists. The winners will be announced at the Ozwater’23 Gala Dinner.
R&D EXCELLENCE AWARD
• Real Greenhouse Gas Emission Measurement and Reporting for Real Reductions as We Move Toward Net Zero Melbourne Water, University of Queensland, University of Melbourne and Ektimo (Vic)
• Driving Circular Economy in the Red Meat Industry Tessele Consultants (WA)
• Water Conservation for Remote Dialysis Purple House and Department of Agriculture, Water and the Environment (NT)
• CRC-P: Transforming Wastewater Treatment in Regional Australia Urban Utilities, Australian Centre for Water and Environmental Biotechnology, University of Queensland, Power and Water Corporation, Department of Environment and Science, and Aquatec Maxcon (Qld)
• Goyder Institute Healthy Coorong, Healthy Basin Research Plan Department for Environment and Water, Flinders University, University of Adelaide, University of South Australia and other contributing organisations (SA)
• Collaborative Research Project for NOM Reduction Through Catalytic Advanced Oxidation Infinite Water and Sydney Water (NSW
• Town Water Risk Reduction Program

Department of Planning and Environment (NSW)
• BasinGuide – Promoting River Basin-Scale Approaches for Prosperity and Sustainability in the Indo-Pacific Alluvium and Australian Water Partnership (ACT)
ORGANISATIONAL EXCELLENCE AWARD
• Enhancing Liveability and Prosperity in the Goulburn Valley Goulburn Valley Water (Vic)
• 2022 Gnangara Groundwater Allocation Plan Department of Water and Environmental Regulation (WA)
• Drinking Water Quality Management System Improvement: 2016 to 2021 Power and Water Corporation (NT)

• Fulton Hogan Utilities Schools STEM and Industry Immersion Program Fulton Hogan Utilities (Qld)
• Activating South Australia’s Reservoir Reserves for Recreation SA Water (SA)

INFRASTRUCTURE PROJECT INNOVATION AWARD (REGIONAL)
• Design and Construction of the Mt Cole Pipeline Renewal GWMWater and Interflow (Vic)

• Remote Housing Program –Headworks Power and Water Corporation (NT)
• Cleveland Bay Purification Plant Process Upgrade Project AECOM, Townsville City Council, Beca HunterH2O, Evoqua Water Technologies and Monadelphous Engineering (Qld)
Proudly
NATIONAL SPONSOR: 22 Ozwater’23 Discover more. awa.asn.au
Proudly sponsored by:
sponsored by:
Check awa.asn.au and subscribe to Source to see the winners
• Pike Floodplain Inundation Measures Project (South Australian Riverland Floodplains Integrated Infrastructure Program)
Department for Environment and Water, the Jacobs Group and SA Water (SA)
• Launceston Network Flow Survey and Hydraulic Model Build and Calibration
TasWater, WSP and ADS Environmental Services (Tas)
• Jubullum Aboriginal Community Water Project
Department of Planning and Environment, Clarence Valley Council and EcoTeam (NSW)
INFRASTRUCTURE PROJECT INNOVATION AWARD (METRO)
• Shakespeare Grove Main Drain Outlet Renewal
Melbourne Water, Stantec and John Holland-KBR Joint Venture (Vic)
• Neerabup Groundwater Scheme Expansion
GHD, Sacyr, Water Corporation and Westforce Construction (WA)

• Australia’s First Biosolids Gasification Facility
Logan Water Partnership: Logan Water, Downer, WSP and Cardno now Stantec and ARENA (Qld)
• Victoria Park Pakapanthi Wetland Tonkin Consulting and DesignFlow (SA)
• Balickera Tunnel Restoration Hunter Water, Abergeldie Complex Infrastructure and Tunnelling Solutions (NSW)

• Integration of Ecological Response Feedbacks for Optimisation of Water Resource Management Rebecca Carlier, University of Newcastle (NSW)
• Natural Recreational Swimming Sites Along the Murrumbidgee River Ana Maria Londono Botero, Australian National University (ACT)
STUDENT WATER PRIZE
• Turning Waste into a Resource: Developing Novel End-Use Pathways for Water Treatment Sludge
Minh Duc Nguyen, Deakin University (Vic)
• Catching Collie’s Future
Irina Sankoff, Murdoch University (WA)
• Carbon Cycling Through Wetlands and Streams in the Wet-Dry Tropics
Vanessa Solano, Charles Darwin University (NT)
• Novel Disinfection to Combat Antibiotic Resistance


Zhigang Yu, University of Queensland (Qld)
• Quantification of Greenhouse Gas Emissions from Sludge-Drying Lagoons and Strategies for Methane Emission Mitigation
Sarah Aucote, SA Water and University of Queensland (SA)
AUSTRALIAN STOCKHOLM JUNIOR WATER PRIZE
Winner announced at Ozwater’23 Gala Dinner
BEST WATER E-JOURNAL PAPER –IN HONOUR OF GUY PARKER
Winner announced at Ozwater’23 Gala Dinner
Proudly sponsored by: Proudly sponsored by: Proudly sponsored by: Proudly sponsored by: 23 Australian Water Association Awards
awa.asn.au
AUSTRALIAN WATER AWARDS
YOUNG WATER PROFESSIONAL OF THE YEAR AWARD
• Sian Harrick Process Engineer, Arup (Vic)
• Phillip Meng Senior Analyst – Data Products, Water Corporation (WA)
• Daniel Lane Senior Chemical Engineer, Trop Water (NT)
• Johanna Johnson Sustainable Solutions Lead, Logan Water (Qld)
• Loreline Kerlidou Principal Consultant, Inside Infrastructure (a Ricardo Company) (SA)
• Akira Weller-Wong Estuary Scientist, Derwent Estuary Program (Tas)

• Chelsea Hayward Senior Process Engineer, Jacobs (NSW)
• Curtis Gordon Operations Engineer, Icon Water (ACT)
WATER PROFESSIONAL OF THE YEAR AWARD
• Nina Braid Aboriginal Partnerships Manager, Yarra Valley Water (Vic)
• Terry Ward Technical Director – Water, GHD (NT)
•Emma O’Neill Manager – Environment & Planning, Aurecon (Qld)
• David Howard Business Development and Strategy Manager, Fulton Hogan Utilities (SA)
• Tim Gardner Chairman, Stornoway (Tas)
• Ian Law Principal, IBL Solutions (NSW)
• Tony Slatyer Water Policy and Governance Consultant (ACT)
Proudly sponsored by:
WATER INDUSTRY SAFETY EXCELLENCE AWARD
• Ventia and Yarra Valley Water Tank Inspection and Maintenance Program Ventia (Vic)
• Sunwater Best Practice Injury Management System Sunwater (Qld)
• Epsom Main Sewer Relining Melbourne Water (Vic)
• Always Safe Initiative Southern Rural Water (Vic)
• Remote Switching Finger Veolia (NSW)
• Lockerbie Main Sewer Project Lifting Methodology Yarra Valley Water (Vic)
Proudly sponsored by:
NATIONAL SPONSOR: Discover more.
CUSTOMER EXPERIENCE AWARD
• Building better together: Embedding CX/UX practice into Digital Transformation SA Water (SA)

• Customer insights driving strategic outcomes and planning SA Water (SA)

• Leak Alert Program South East Water (Vic)
• Weathering the Storm Watercare (NZ)
Proudly sponsored by:
Proudly sponsored by: 24 Ozwater’23
STATE & TERRITORY WINNERS



We look forward to celebrating the outstanding achievements of all our national awards finalists at the Ozwater’23 Gala Dinner on 11 May.






SA ACT NT
25 Australian Water Association Awards
QLD TAS NSW
WA VIC
MOVING ON UP


Next steps for career progression aren’t always clear. But as the AWA mentoring partnership between Natalie Muir and Chantal Keane shows, pairing up can help illuminate the pathway forward.




 By Cecilia Harris
By Cecilia Harris
26 Ozwater’23 Discover more. awa.asn.au
MENTOR: Natalie Muir, 46
CURRENT ROLE: Stantec
EXPERIENCE: 26 years
CHANTAL KEANE
FUTURES SPECIALIST CIRCULAR ECONOMY URBAN UTILITIES
When Natalie and I were in the middle of our mentoring relationship, I was a trade waste officer for Urban Utilities. I looked after industrial customers and made sure they were compliant with their wastewater discharge. It was an interesting job. But I’ve moved into a new role now in circular economy strategy and planning. I talk to a whole range of different people about net zero, climate change and water security.
she’s a good listener, so it was a great match.
I didn’t have any really big challenges at the time. But I was a bit uncertain about where to go next, or how to get there. I’m in the early stages of my career. And I do believe that age plays a role in when you can become a leader or a manager in your career. So the things I asked her were about what I could do to prepare myself in the meantime. I sought her advice on what would prepare me for management roles, and the types of skills I could be honing.
Natalie is the epitome of success, so I’m going to trust her advice.
MENTEE: Chantal Keane, 25


CURRENT ROLE: Urban Utilities
EXPERIENCE: 5 years
I got involved in mentoring because I had a bit of spare time. I’d learned a lot in my past role, but I was keen to see what I could do to upskill or progress in my career further. I’ve been involved in a couple of leadership and management programs, which is definitely an area that interests me. I thought having a mentor could help steer me into the next phase, so I signed up to see where it might take me.
FINDING BALANCE
Natalie works with Stantec, and it was really great to be paired with someone from a different company. But I was also really excited to be paired with a woman mentor. I’ve had a couple of male mentors already, just by chance, but I was interested in getting the other perspective. Women can have different priorities and experiences, and I was interested to learn from Natalie because she has been so successful. We talked about everything. I’m a real chatterbox and
But some of the chats we had were about work/life balance, too. Natalie encouraged me to be ambitious, but also to make sure I’m not overdoing it. Natalie’s busy with a young family, and has this amazing career, but she is also very calm and chilled out. I can understand why she’s been successful. Her presence is very reassuring. I learned a lot simply from the way she interacted with me.
HIDDEN PERKS
Participating in the mentoring program had a few unforeseen benefits. Urban Utilities runs young water professional events with other water sector companies. I went to a few events and I kept running into Natalie, which I didn’t see coming. But Natalie very generously introduced me to heaps of people in the industry. It was so nice. Having her as a mentor naturally turned into a networking opportunity, which is really valuable.
The mentoring relationship Natalie and I developed in the program felt different to my other mentoring experiences. It went further than advice. I would definitely recommend that all young water professionals seek mentoring at some stage. It’s an amazing opportunity to be given one-on-one time with a mentor – they are all busy people.
And I think young water professionals need to make the most of these special opportunities.
27 Australian Water Association Mentoring
Pic
Credit: Russell Shakespeare
We talked about everything. I’m a real chatterbox and she’s a good listener, so it was a great match.
Chantal Keane
“
NATALIE MUIR
REGIONAL DIRECTOR, ENVIRONMENT & GEOSCIENCES AUSTRALIA CLIMATE SOLUTIONS LEADER, ANZ STANTEC
This is my first experience with the Association’s mentoring program. I have done mentoring within Stantec (previously Cardno), so I’ve had a few mentees. I saw the program as a good opportunity to mentor someone from outside my own business. I’d also heard great things about the program.
I’d say I’m in the ‘giving back’ phase of my career. I’ve been in the industry for a long time and a member with AWA for about 25 years. And I am very much in that phase of wanting to share what I’ve learned with others, to contribute to the sector, and mentoring is a great way to do it. There’s lots of amazing young water professionals out there, too, so I also saw it as a chance to meet some different young people, to encourage them and share with them what has helped me in my career.
NEXT STEPS
After spending some time getting to know Chantal, it was clear to me that she’s a high-achiever. Chantal is one of those young people that you just know is going to go a long way in their career. I wasn’t really sure what I was going to be able to offer her in terms of guidance and support. But

after a bit more conversation about our experiences, I learned that she was working in a role she enjoyed a lot, but had reached a point where she’d learned everything there was to learn. She needed more of a challenge.
Chantal and I spent most of our time talking through what her next steps might be. I shared the experience I’ve had in my career with her, and gave her some advice and ideas about how she might approach taking on a new role. Turns out, Urban Utilities were thrilled to offer her an exciting new gig, a role in which she could keep growing and learning, which is fantastic.
Chantal knows how to put herself out there. When it comes to progressing, she’s doing everything right. She’s diligent and driven, and I’m absolutely certain she will succeed in whatever she chooses to do.
NEW PERSPECTIVES
One of the great things I gained from my partnership with Chantal is the insight it gave me into other areas of the water sector. I’m an engineer and I mentor a lot of engineers, particularly female engineers. But Chantal comes from a scientific background and was working in a different part of the water sector. It was actually really valuable to gain that different perspective.
It reminded me that when talking about female participation in the industry, we need to ensure we use a broad lens. There’s lots of great opportunities for women of every background in water. Mentoring is very much a two-way relationship. I have lots of experience to share, but Chantal has her own unique perspective to share with me, too. As a mentor, you always learn something.
The AWA mentoring program is a great way to meet different people in the water industry, particularly some of our future superstars. I’m continually inspired by the things that young professionals do and achieve. I’ve found my experience with the program to be really uplifting; it’s reassuring to know the future’s in such good hands.
28 Ozwater’23 Discover more. awa.asn.au
Chantal was working in a different area to me, and it was actually really valuable to gain that different perspective from within the sector.
“
Natalie Muir
GETTING THE MOST OUT OF WATER TRANSPORTATION BEGINS WITH THE RIGHT PIPELINE
When critical water or wastewater transport is essential to the success of your project, helping you get there is what we’re here for. Steel Mains provides only the highest quality pipelines through our innovative Sintakote® Steel Pipeline System

Backed by 150 years experience, our pipelines have been trusted for generations and our capability has been proven in all the major water projects our pipelines have served.
Through our cutting edge corrosion systems, our Sintakote® Steel Pipeline System has an enviable 150 years’ service life to match. Choose Steel Mains for your next pipeline project.
www.steelmains.com
More than a steel pipe supplier









As the next wave of water reform looms in Australia, Current takes a look at what’s driving the renewed federal focus on the environment and First Nations Voice, and what it might mean for the water community.






















Sustainability, water management and preservation 32 SHAPING OUR WATER FUTURE
To discover more environment
40 VOICE TO PARLIAMENT Dr Phil Duncan discusses the importance of the upcoming referendum. 44 COSTING CLIMATE Why resilience is essential to curbing the economic impact of climate change. 50 UNDERSTANDING CATCHMENTS Millenium Drought data builds a deeper understanding of rainfall runo relationships. 31
news, visit awa.asn.au/news
Current investigates what’s driving the latest changes in water reform and how a resurrected federal focus will affect local water management, increasingly dramatic environmental issues and the long-discussed matter of First Nations water rights.

 By Chris Sheedy
By Chris Sheedy
Discover more. awa.asn.au 32
Following the Labor Party’s federal election win in May 2022, national discussions turned quickly to water, with incumbent Minister for the Environment and Water Tanya Plibersek announcing the new government’s intention to ramp up federal focus on reform.
“When it comes to sustainable water management and water security, national leadership is needed now more than ever,” Plibersek said during her inaugural address.
“Our government will work with you to deliver real action on climate change, increase First Nations participation in water management and deliver the Basin Plan as intended.”
With the 2021 State of the Environment report delivering the sobering message that, overall, the state of the environment in Australia is “poor and deteriorating”, the shift to an environmental and First Nations focus couldn’t have come fast enough for many within the water community.
On 23 February 2023, the government announced $424 million in additional funding towards essential services for Aboriginal and Torres Strait Islander communities under its second Closing the Gap Implementation Plan, including $150 million in support of First Nations’ water infrastructure to provide safe and reliable provision.
“In a country like Australia, it is shocking that there are still communities who don’t have a clean and reliable source of drinking water. Many of these communities are remote, First Nations communities. We want to start to change that with this investment,” Plibersek said.
With Australia now on the cusp of major water reforms, many areas of management are considering where these shifts might lead and how to
take full advantage of the transition for lasting, positive change.
FIRST THOUGHTS
Right now, the coming together of a number of circumstances is likely to produce significant improvements in the way water is managed in Australia, according to Dr Susan Close, Deputy Premier of South Australia and Minister for Climate, Environment and Water.
“One of these is that we now have, from my political perspective, a Federal Government that is far more willing to engage in proper reform,” Close said.
“Another is the understanding of the impact and threat of climate change. A third element is the recent floods, which have focused attention on water like has not happened since the Millennium Drought.
“Water is a complex policy area that changes in multiple iterations over time. But I’ve got quite a lot of hope that we will see some substantial and lasting improvement.”
Indeed, Australia’s water reform journey has a history of twists and turns. But the recent change of government has brought with it a federal onus and increased funding for National Water Grid projects.
“South Australia is a small state in population, but a large state in geography,” Close said. “We’re a very dry state. We are acutely sensitive to the complexities of water, and we don’t automatically trust that people outside of South Australia will have our interests at heart.
“But at the same time, I genuinely believe that true water reform, as with most reform, needs to happen at the federal level, but with state support.”
Joanne Chong, Commissioner at the Productivity Commission, agrees that this is an excellent opportunity for improvement on top of the work done over the last few decades.
“There have been significant benefits and advancements because of the National Water Initiative,” Chong said.
“There is great energy and interest around renewal. There have been achievements that need to be locked in, and the goals, objectives and elements modernised.”
FUTURE REFORM MUST REFLECT PAST LESSONS


As outlined in the Productivity Commission’s National Water Reform 2020 report, jurisdictions have made good progress against the reform agenda outlined by the almost two-decades-old National Water Initiative (NWI).
Material benefits came from these reforms, including more efficient and sustainable water resource management, lower average water use by households, more efficient use by industry, more water for the environment and better adaptation to uncertainty.
Water is a complex policy area that changes in multiple iterations over time. But I’ve got quite a lot of hope that we will see some substantial and lasting improvement.
33 Australian Water Association Environment
Dr Susan Close, Deputy Premier of South Australia and Minister for Climate, Environment and Water
A strong water market has also developed, with trading turnover in 2018-19 estimated at $5.2 billion.


But for water reform to continue to be effective, the Productivity Commission report said: “…it needs to be adaptive – reflecting lessons learnt from experience, evolving as the broader policy context changes and proactively dealing with anticipated challenges”.







There have been many lessons over the life of the NWI, particularly around the management of the Murray Darling Basin.

Increasingly severe droughts and floods, water restrictions, recognition of a lack of quality engagement with Traditional Owners, declining streamflows and more have combined to highlight the need for new water reforms.

FIRST NATIONS ENGAGEMENT


The Productivity Commission’s 2020 report recommended that a renewed NWI should better address Aboriginal and Torres Strait Islander people’s desire to participate in all significant processes and decisions related to water resource management. In the water sector there has also been growing recognition of Traditional Knowledge in managing water and land systems, Chong said.
“There is an increased appreciation of Indigenous Knowledge systems that are so connected to culture. And those involved in managing, using and planning for water resources have long realised that the best solutions don’t arise from applying knowledge in silos,” she said.
AUSTRALIA’S WATER REFORM JOURNEY


Bradley Moggridge, Associate Professor in Indigenous Water Science at the University of Canberra, said the original NWI document was the first time a national policy document mentioned Aboriginal people with regards to water.






But that’s where the benefits ended. Moggridge was also a co-lead author of the Inland Water chapter of the 2021 State of the Environment report, which told a grim story of degradation, poor water quality and quantity, and limited rights to water.


“Water was taken off us, and now there’s a water market that created a mechanism for the separation of land and water,” Moggridge said.
“For my Elders, if they didn’t have land, they didn’t get water under water management laws. Then, when land and water were decoupled







The Council of Australian Governments set up a water reform framework to balance the allocation of water between states and territories, maintain the health and viability of river systems and groundwater basins, establish principlebased pricing reform and address service delivery ine ciencies.
The Millennium Drought began.




To build upon the 1994 water reform framework, the National Water Initiative was developed and the National Water Commission was established.

The MurrayDarling Basin recorded the lowest inflows on record, as the Millenium Drought continued to intensify.
The Water Act 2007 established a legislative framework for the allocation and management of water resources in the MurrayDarling Basin, with the intention of ensuring the basin is managed in the national interest.
1994 1997 2004 2006 2007 34 Discover
Ozwater’23
more. awa.asn.au
through the implementation of the NWI, this further disenfranchised Aboriginal people in terms of access to water rights. So, we started off behind the eight ball, and now we’re not even in the same room as the pool table.”
Moggridge said he’s still waiting to find out what the NWI refresh means for First Nations people: “I suppose our push will be to make sure we can get more access to water than Native Title provides,” he said.
“We know Native Title doesn’t work because it doesn’t give you rights to water. So how is water law going to change with the new National Water Initiative to ensure actual benefits for Aboriginal people?”




BASIN BLUES

A new water reform initiative should influence change on a number of levels, but management challenges should be met with contemporary solutions to ensure advancement in process and functionality.
“We are very interested in deep reform that is modernised and effective,” Close said.

Top-of-mind issues for South Australia include the Murray-Darling Basin Plan (MDBP) and First Nations water rights, she said.





Sustainable diversion limits were introduced to the Basin Plan following a review of the environmental watering strategy.
The Productivity Commission’s National Water Reform 2020 reported on progress under the NWI, suggesting important changes related to climate change, First Nations engagement and national regulatory frameworks.










The change in Federal Government has brought a new focus on water reform. The Department of Climate Change, Energy, the Environment and Water was established and the National Water Commission’s resurrection was proposed.
 An almost empty farm dam in rural Australia, cracked and eroded from years of drought followed by heavy rains.
A large agricultural irrigation dam turned to salt due to drought in Australia.
An almost empty farm dam in rural Australia, cracked and eroded from years of drought followed by heavy rains.
A large agricultural irrigation dam turned to salt due to drought in Australia.
There have been achievements that need to be locked in, and the goals and objectives must be modernised in terms of the current situation.
Joanne Chong, Commissioner, Productivity Commission
The National Water Commission was abolished, with key functions transferred to other government agencies.
2020 2022 Environment Australian Water Association 35
The Basin Plan, outlining a strategy to return water to the environment in the Murray-Darling Basin, passed through parliament with support of all major parties.
2012 2014 2019














Disinfection made simple, with OSEC® Onsite electro-chlorination is a proven and effective disinfection process. With just the salt to be handled, chemical risks are reduced and there is no need for large storage footprint as the sodium hypochlorite is generated on demand. Contact us today to find out more 1300 661 809 info.au@evoqua.com evoqua.com/OSEC
“There’s a very real threat … that we will not deliver the MurrayDarling Basin Plan,” she said. “That is unacceptable to us, and I believe it’s unacceptable to the incoming Federal Government. So any water reform initiatives that intersect with the Murray Darling Basin Plan are significant for us.
“And we will be extremely alert to the interaction with First Nations water rights, specifically around how we continue to close the gap, ensuring Aboriginal communities have access to good quality water.”
Then there’s the question of climate change, which Close said hasn’t been properly accounted for in the MDBP.

“The lack of recognition of the latest climate change science in the Murray-Darling Basin Plan is something we want fixed,” she said.





“We will speak up for ourselves in South Australia, and for our end of the Murray-Darling Basin, and we will scrutinise every policy perspective of whether it addresses the challenges that we experience in our particular circumstances.

“But, with all of that said, I do think that the reintroduction of federal interest in this is very welcome.”

CLOSING THE GAP
Released alongside the Coalition of Aboriginal and Torres Strait Islander Peak Organisations’ annual Implementation Plan, the 2023 Commonwealth Closing the Gap Implementation Plan and additional $424 million in allocated funding has been the latest step in the government’s reform agenda, with a significant focus on water.



We know Native Title doesn’t work because it doesn’t give you rights to water. So how is water law going to change with the new National Water Initiative to ensure actual benefits for Aboriginal people?
Bradley
Moggridge, Associate Professor in Indigenous Water Science, University of Canberra
37 Australian Water Association Environment
Flooded Gurra Gurra floodplain on the Murray River.
Conference in August 2022 on the challenges facing First Nations communities due to the inadequate provision of essential services, said the new funding is urgently needed.



“We have decades of underinvestment in our communities and organisations to be addressed, and this funding will go some way to overturning that,” she said. “It is critical that the new investment is delivered in line with the priority reforms and through formal partnerships between government and communities and organisations on the ground.”
The plan aims to provide direction on transforming government in line with the National Agreement on Closing the Gap’s four priority reforms, including formal partnerships between government and Aboriginal and Torres Strait Islander communities on policies and programs that have a significant impact on them.
While the government allocated $150 million in additional funding for First Nations’ water infrastructure, the other $274

additional
million has been earmarked













prevention and support, onCountry education programs and boarding for remote students.



Minister for Indigenous Australians Linda Burney said a lot of the foundational work has been done over the last two years and the government is now focusing its efforts towards real and lasting change.





“We saw the outcomes in the 2022 Closing the Gap Annual Report and know that we need to be doing more as a government,” she said.
“Our measures are going to be more specific and more targeted, making real impacts that complement work underway in states and territories, and backin Aboriginal and Torres Strait Islander community-controlled organisations to lead work in their communities.”
The government’s commitment to holding a referendum to enshrine a First Nations Voice to Parliament in the constitution is a good start.
WHY THE MURRAY-DARLING BASIN PLAN GETS ITS OWN REVIEW
Why is there a National Water Initiative review and a separate review of the Murray-Darling Basin Plan? Because the basin is a region that is recognised as Australia’s most important in terms of water management.


The basin is home to 16 internationally significant wetlands, 35 endangered species and 120 species of waterbirds. It accommodates people from more than 40 di erent First Nations, part of a human population in the basin now numbering 2.3 million.

It’s a region that produces about 40% of the nation’s agricultural produce, 100% of our rice and 74% of our grapes.
The Productivity Commission is due to execute its five-yearly assessment of the Murray-Darling Basin Authority’s implementation of the plan, with the next inquiry report to be released later this year.

38 Discover more. awa.asn.au Ozwater’23
Pat Turner AM, who spoke at the AWA/WSAA Voices for the Bush
for new remote housing, food security, family violence
WATER FOR DEVELOPMENT PROGRAM



In partnership with the Australian Government and AWA members, we connect Australian water expertise and technology with the water-sector needs of our Indo-Pacific partner nations. With our partners, we build capacity, delivering sustained improvements in water networks, working together to achieve Sustainable Development Goals (SDGs) in Vietnam, Cambodia, Indonesia, and the Pacific.
Connects AWA members with development opportunities internationally including facilitation of 25+ South-East Asia delegates and promotion of Australian innovation through our 500 national water professionals.











Builds strong, enduring partnerships with the Australian Government and international associations.








Creates measurable watersector outcomes in the Indo-Pacific through pairing of 26 water utilities to improve service delivery to over 20 million customers.


Contributes to mutual learning, building collective impact and developing scholarship programs and facilitating young water professionals.
Supports our international partners to build climate resilience through knowledge exchange programs and association-to-association collaboration.
If your organisation wants to support development outcomes and the achievement of SDGs in South East Asia and the Pacific, please contact our Head of International and Industry Programs, Sally Armstrong. Email: sarmstrong@awa.asn.au

























VOICE FOR THE FUTURE
Forty years of working to improve the lives and lands of Aboriginal people has convinced Gomeroi man and water industry leader Dr Phil Duncan that a First Nations Voice to Parliament is the way forward.

“For the first five years of my life in this country, I wasn’t recognised as a human being,” he said. “The 1967 referendum decided that I was no longer considered flora and fauna. Getting involved as a supporter and an advocate for the Uluru Statement from the Heart, and the journey towards constitutional reform through a referendum is something that I’m very passionate about.”
CHARTING A COURSE
The referendum is set to be held between August and November this year, and will ask whether Australians wish to change the constitution to recognise Aboriginal and Torres Strait Islander people through the establishment of a representative Voice to guide parliamentary and government decisions.
“It’s time for this country to do what’s right,” Duncan said, urging people to inform themselves on the issues and consider the future through the eyes of the next generations.
“Don’t vote yes because you feel it’s an obligation – become a supporter because it’s the right thing to do,” he said.
“We will be judged by our next generations in terms of what we leave them – environmentally, and as a cohesive society that has a shared vision of a prosperous and reconciled future for all to enjoy.”
SOURCE OF LIFE

Duncan said Aboriginal representation at the decision-making table will also be critical for the water sector.
“Water is central to our cultural way of life, our health, our longevity,” he said. “I believe the Voice can play a significant role in the reconvening of land and water so that we are talking about Country in a holistic manner.”
With the Murray-Darling Basin Plan set for review in 2024 and a $40 million fund for First Nations communities to invest in water, Duncan highlights the urgency of that parliamentary Voice.
“We need a framework that creates equal access for Indigenous interests, resourcing us effectively to be active in water markets, planning and the wider management and allocation industry,” he said. “If we miss this opportunity, the water sector may never see it again.”

Dr Phil Duncan urges Australians to vote “yes” on the Voice to Parliament referendum – not out of obligation, but because it’s the right thing to do.
I believe the Voice can play a significant role in the reconvening of land and water so that we are talking about Country in a holistic manner.
“
40 Ozwater'23 Discover more. awa.asn.au Next Wave
Dr Phil Duncan is a Gomeroi man with strong bloodline connections to the Wiradjuri Nation. Duncan is an Adjunct Industry Fellow with the Australian Rivers Institute and member of the Natural Resources Access Regulator’s independent board, and currently acting CEO of the Economic Participation of Indigenous Communities CRC bid. In 2022, Duncan was awarded an honorary doctorate by Griffith University in recognition of four decades of work protecting waterways, and preserving Indigenous knowledge and education.
24 Locations in Australia
350+ Water professionals in Australia
4,000+ Water professionals worldwide Together we provide the full range of water and environmental services to support our clients and communities across Australia. Find out more stantec.com/australia

















Your next career move could be
the
your future with us. Scan to learn more about working at Interflow.
just around
corner Create
CURBING THE COST OF CLIMATE CHANGE

As a number of new reports highlight the rising cost of climate inaction, building resilience is essential to curbing the economic impact of water risk in Australia.





 to
to









 By Elle Hardy
By Elle Hardy
Discover more. awa.asn.au 44
In the event we needed any further evidence of the steep cost of climate change, a number of recent studies have starkly laid out the challenges.
The Intergovernmental Panel on Climate Change (IPCC) recently revealed that over half of all natural disasters worldwide since the 1970s have involved water, while consultancy group GHD’s 2022 Aquanomics report found that water risk (droughts, floods and storms) could result in a total loss of $312 billion to Australia’s GDP between 2022 and 2050, almost one third of Australia’s GDP in 2020, with $6 billion in losses expected for utilities.



Building resilience is identified as key to curbing the cost of these water risks, with the water community positioned to play a crucial role in terms of adapting to climate, optimising existing infrastructure and prioritising the circular economy.
GHD Australian Market Leader in Water Lindsey Brown said that GHD’s Aquanomics report is the first time the economic impact of droughts, floods and storms have been calculated at a GDP and sector level.
“Our report reveals storms are expected to have the greatest direct impact on the Australian economy [$102 billion], followed by floods [$64 billion] and droughts [$41 billion],” she said. “These rising threats need to be tackled now, with greater focus on solutions like water recycling, desalination and smarter irrigation.”
Brown said it’s time to move away from viewing water as a commodity to be controlled, and instead recognise its intrinsic value – that water is part of a natural cycle, the balance of which must be restored and maintained if we are to live sustainably and prosper.
“To create resilience to the increasing risks from extreme weather events, we need to adapt how we build water infrastructure, optimise the performance of existing infrastructure and prioritise nature-based solutions
to water management across industries,” she said.
CIRCULAR ECONOMIES


With a growing population and increasing demand for water, embracing the circular economy is a key part of creating climate resilience in Australia, Brown said.
A circular economy approach to water management includes options such as supporting water authorities to design out waste and pollution, and regenerate natural systems. Increasing supplies of manufactured water through water reuse and recycling also offers a reliable source of water that is not climatedependent and can contribute to wider decarbonisation efforts through green hydrogen production.
Brown added that for Australia’s coastal cities – where 80% of the country’s population is concentrated – desalination will be crucial in easing water stress, and inland, wastewater treatment and recycling will become more important.
“These processes make purified recycled water available for drinking and for use by power stations, industry and agriculture,” she said. “The government also has a key role to play in managing the transition to
These rising threats need to be tackled now, with greater focus on solutions like water recycling, desalination and smarter irrigation.
45 Australian Water Association Environment
Lindsey Brown, Australian Market Leader in Water, GHD




























Are you prepared for AS/NZS 61439 switchboard standards? Don’t be left behind. NHP’s Cubic Modular switchboard systems and Concept distribution panelboards will ensure you’re compliant with the new standards. For the complete 61439 switchboard solution, call your local NHP Account Representative on 1300 NHP NHP or go to nhp.com.au/61439
new methods of water management. Investment programs, such as the National Water Grid Fund, are the first step, but infrastructure can be only part of the solution.”
Brown believes that while the water industry is already evolving to meet the need for climate action, it needs to continue to embrace change.
“Despite our best attempts to quantify the financial and economic impact, as we have in our Aquanomics report, we can’t put a price on the psychological and emotional impact on communities affected by climate-related events. There are new roles and expectations, where water companies do not only have to provide water and wastewater services, but must also care for the environment and the wellbeing of the communities they serve, while reducing their carbon emissions and ensuring their services are resilient.”
Pleasingly, Brown said the Australian water sector already sees itself as an enormous driver of community value, and has been quick to take on the responsibility of responding to these emerging issues to provide value to the community and continue to enjoy a licence to operate. This also presents an opportunity for the water sector to attract and retain talent that shares the purpose and commitment to respond to these challenges.
“In the end, water utilities exist to serve their communities, so it’s important that we shine a light on these issues, the impact they have on people and the opportunities they present.”
RISKY NEXUS
Dr Russell Wise, CSIRO’s Principal Sustainability Economist for the environment, agrees that the water sector can take a leadership role in driving widespread, systems-based approaches to the way decisions are made, particularly in regard to interdependent infrastructure.
“Water systems are tightly dependent upon energy systems
and infrastructure systems and smart telecommunications – yet the governance of these systems is largely independent,” he said.

One example of this is the town of Cobargo in regional NSW, which was severely affected by the bushfires of 2019-20.
“Talking to community members, one of the less obvious but significant impacts of the fires was the fact they had no power during the event and for an extended period afterwards,” he said.
“This prevented them from being able to protect many of the buildings that were lost to the fires because they couldn’t pump any water. Afterwards, they were unable to safely return to their homes because they had no fresh water or working sewerage system.”
Part of the town’s recovery plan is now built around disaster-resilient,

renewable micro-energy systems that make the town ‘islandable’ in the event of bushfires and ensure the continued supply of freshwater and wastewater services.
GOING MODULAR

Wise believes the industry can look to new decentralisation-enabling technologies when it comes to promoting water resilience.
“If one part of a decentralised water system fails, other parts continue operating. But when vertical hierarchies collapse, failure is often catastrophic,” he said. “Decentralised water systems are frequently more resilient than a single central plant, yet historically there has been a tendency to default to more centralised ‘top-down’ management and governance.”
Wise said large wastewater treatment plants may take months
If one part of a decentralised water system fails, other parts continue operating. But when vertical hierarchies collapse, failure is often catastrophic.
Dr Russell Wise, Principal Sustainability Economist, CSIRO
47 Australian Water Association Environment
Flood waters rise in Brisbane.
to restart in the case of shutdowns, and points to a small plant on the island of Saint Thomas in the Virgin Islands to illustrate the resilience built into decentralisation.
“After a category 5 hurricane, the rest of the island waited months for resumption of service, while an energy-efficient, decentralised treatment technology plant from Fluence was started within hours of being hooked up to a generator,” he said.



“While decentralised treatment has long been an ideal for water resilience, modular desalination and wastewater treatment units have now made it practical.”



In order to help shift communities away from high-risk situations towards disaster-resilient futures, the CSIRO, in partnership with










Value Advisory Partners and the University of Adelaide, has come up with an investment planning and analysis framework called Enabling Resilience Investment. The toolkit aims to help inform choices and interventions to reduce climate and disaster risks, using resilience to generate new value. Discussing true resilience in the face of climate risk, Wise said it
is not about resisting change and continually bouncing back to the same thing when disrupted.




“Doing so can be extremely counter-productive if the causes and occurrences of the disruption are relentless, continually increasing in magnitude, and when resistance and bouncing back perpetuates the vulnerabilities or creates negative effects for others,” he said.

StandU07 1300 625 562 sales@allmach.com.au www.allmach.com.au Reliable & Quality Water Treatment Solutions Piping Systems Dual Containment Hose Stainless & Carbon Steel, Aluminium, Poly & PVC C M Y CM MY CY CMY K
Drought after flood in a soy bean field
Discover more. awa.asn.au
Morphum Environmental’s approach to Integrated Water Management (IWM) planning begins by breaking down the barriers to gain a comprehensive understanding


of your urban network



Our unique approach to IWM ensures that your water network is effective, spatially connected, and the foundations are robust from the outset. Our five-step process takes an in-depth examination of your piped network, ensuring the fundamental data is established and an effective IWM plan can be achieved. We undertake this by utilising GIS network analysis, data integration, environmental engineering, and
best-practice asset management that allows for continuous improvement and successful IWM outcomes well into the future.
To find out how to get your piped network set up correctly, contact our team or visit the website to learn more.



p. 03 9111 5640 | morphum.com.au









IMPORTANT!
EFFECTIVE IWM IS NO LONGER A PIPE DREAM
CASE STUDY #1
RAINFALL RUNOFF RELATIONSHIPS
PROJECT: Explaining rainfull runoff relationships
REGION: Australia
STARTED: Ongoing
LEADER: University of Melbourne
Areas of southern Australia face the prospect of increasingly severe and frequent droughts as key water resource planning is affected by changes in climate and catchment hydrology.
 By Martin Kovacs
By Martin Kovacs
With a lack of data an impediment to seeking out historical analogues, the Millennium Drought is an important area of focus for research into changed catchment rainfall runoff relationships.
Dr Keirnan Fowler, Hydrology Infrastructure Engineering Senior
Research Fellow at the University of Melbourne said building an understanding of hydrological shifts resulting from multi-year drought events can help to better inform planning and management strategies that address the challenges presented by long-term drying.
The research paper, Explaining changes in rainfall-runoff relationships during and after Australia’s Millennium Drought: a community perspective was published last year. It
Reservoir in South Australia reducing due to extreme drought.
50 Ozwater’23 Discover more. awa.asn.au
employs a multi-disciplinary approach in exploring why hydrological shifts occurred in the Millennium Drought.
Fowler, who collaborated with 32 other researchers in a staged process commencing with a virtual workshop in late 2020, explained that hydrologists “look for the closest analogue to those future conditions among our history”.
This is especially important in the context of the significantly lower-than-expected streamflows experienced during the Millennium Drought – which Fowler noted “really surprised policymakers and water managers” – and the role that modelling will play in future planning.
“If we can understand catchment hydrology response to events like the Millennium Drought, then we’ll have a better chance to understand the response under future changes in climate,” he said.
“And within that change in climate, there will also be relative highs and lows. Future droughts are going to be more frequent and potentially worse in severity than what we’ve yet seen.”
UNEXPECTED BEHAVIOUR
Professor Andrew Western, Head of the University of Melbourne’s Department of Infrastructure Engineering and one of the research co-authors, stressed the importance of studying catchment hydrology in conjunction with the sustained changes in climate-triggering shifts in rainfall runoff relationships.
While hydrologists have been able to identify where and when shifts have occurred, the research points to the lack of a “convincing and widely accepted physical explanation for changes in catchment behaviour”.
“Long-term data records are critical to this sort of work, and one of the limitations that we are facing is

that we have very little information about what is happening inside the catchment,” Western said.
“Understanding catchments might behave differently in a future climate, and having some indication about that level of sensitivity by looking empirically at what happened in the Millennium Drought, is a first step.”
In line with this, the research seeks to shed light on unexpected hydrological behaviour in many catchments during the Millennium Drought, manifested in a “surprisingly low” streamflow, even when taking the low rainfall into account.
Compounding water management issues, many catchments have yet to recover post-drought, with these “shifted catchments” seeing an average rainfall year produce less streamflow today than pre-drought, the research notes.
“We know our catchment models over-predict runoff in very dry conditions. If we understand this over prediction, we can start to factor it into our management,” Western said.
“Taking that next step, and moving towards explaining what’s happening, means we are then able to make some better predictions in the future.”
Out of 24 hypotheses considered, three were found to be plausible, 10 inconsistent with the evidence, and 11 in between, meaning they are plausible yet with reservations.
GOING TO GROUND
The Millennium Drought’s unprecedented length is identified as the primary climatic driver, paired with groundwater processes, including storage declines, altered recharge due to vadose zone expansion, and reduced connection between subsurface and surface water processes.
Fowler said the hypotheses considered plausible involve groundwater, which he described as “a common thread”.
“The essence of the behaviour we’re talking about is the catchments display what we would call long memories,” he said.
“It’s not just about whether you get drought rainfall or not. It’s also about what happened in previous years, and the mechanism by which the catchment remembers those previous years appears to be related to groundwater.”
The research in turn highlights the need to better understand the role of groundwater directly and indirectly in streamflow generation.
Fowler said the advantage of undertaking a large-scale assessment of hydrologic changes is the potential for the conclusions to be applicable across a broad range of scenarios.
“It provides different avenues for future research,” he said “We can go away and develop quantitative modelling methods to explore those ideas further and quantify their role in runoff generation.”
The essence of the behaviour we’re talking about is the catchments display what we would call long memories.
51 Australian Water Association Environment
Professor Andrew Western, Head of the Department of Infrastructure Engineering, University of Melbourne
Advanced sensors support a sustainable water future
A case study on South East Water’s Network Leak Detection program
As an industry, water is grappling with macro-scale challenges. Climate change impacts and increased demand for water mean that utilities are transforming to ensure sufficient supply into the future.
Supply and demand scenarios in Melbourne
As one of the country’s biggest water suppliers and wastewater managers, South East Water delivers more than 136 billion litres of drinking water and collects over 108 billion litres of wastewater annually in Melbourne’s south-east. To ensure long-term water security, enhance customer experience, and optimise assets and operations South East Water embarked on the transformation to a digital utility – bringing together people, processes and technology to scale the deployment of advanced sensors across the network and transitioning to a data driven organisation, backed by a culture of innovation.
As one of South East Water’s top 10 capital projects, the Digital Utility program delivers on the utility’s aims to get the basics right, keep customers informed in a timely manner, improve customer experience and value, and support the community and environment. Through digital meters, South East Water is making a difference in the lives of customers and saving water.
From digital meters to advanced sensors
The Digital Utility program is a business model for improved operation and customer service provision, for now and into the
future. It will leverage granular network, consumption and operational data to support better services and provide greater value to customers and stakeholders. The focus of this transformational program is to deliver sustainable value to customers, through improved services and lower costs over the long term.
A fundamental use case of the Digital Utility program is the reduction of non-revenue water, or leaks across the utility network.
While Australian utilities enjoy a relatively low level of non- revenue water on a global scale, there are huge benefits if we can further reduce even a small percentage of non-revenue water.
2015 2025 2035 2045 2055 2065 Average annual volume (gigalitres) 850 800 750 700 650 600 550 500 450 400 350 0 Medium supply Medium demand Demandrange Lowest approx supply level Highest approx supply level With lower demands and lower climate change impacts, we have enough water until beyond 2065. With
With higher demands and
climate
2028. Did you know that in the lowest supply and highest demand scenario, we’ll have a shortfall of water of over 450 GL by 2065
Andrew Forster-Knight General Manager, Digital Utility
medium demands and medium climate change impacts, we have enough water until around 2043.
high
change impacts, we have enough water until around
Source: Water for a Future-Thriving Melbourne Report, Melbourne Water 2017
An initial focus of the program was the deployment of digital meters which provided South East Water with a unique opportunity to integrate additional sensors to gain better visibility – not only of customer-side usage and leaks, but also of leaks across the utility network. This technological advance is providing South East Water teams and customers with more granular and immediate information about water consumption and losses.
Learnings from early deployments
“Possibly the biggest step change that we’re seeing is embedding additional sensors in digital meters. These are just meters that go on customer properties, but they’ve got miniaturised embedded sensors in them to detect leaks on the network side,” Mr Forster-Knight said.
South East Water currently uses a range of solutions to detect network leaks, with Sotto ® providing a unique opportunity to economically deploy a leak detection solution, at scale. Leveraging the communications and battery of the digital meter, the solution detects vibrations (while minimising false positives) and sends predetermined alerts daily.
Heat maps enable operators to detect potential leaks and narrow down the likely location.


With over 30,000 Sotto ® enabled digital meters currently deployed, the detection and location of water leaks and potential bursts is shifting from reactive to proactive as the sensors are confirmed to detect 88% of network leaks weeks, if not months, ahead of traditional equipment.
An independent report extrapolated trial data to confirm that deploying Sotto ® in every digital meter (for suitable sites) at scale would achieve at least a one percent reduction in nonrevenue water losses, equating to 1.63 GL annually at South East Water. These savings are the result of detecting previously undetectable leaks and detecting leaks early.

• Over 30,000 Sotto® integrated digital meters deployed.


• Able to achieve at least one per cent reduction in non-revenue water losses, equating to 1.63 GL annually.

A network-scale solution
Results of early deployments and analysis undertaken to determine the benefits and economic viability of deploying network leak detection at scale were key inputs into the business case for Digital Utility, a fundamental pillar of South East Water’s Price Submission 2023-28. South East Water will now progress to roll out digital meters, 600,000 of which will be integrated with Sotto ® to be deployed over the 5-year period.
To support the utility in managing data from the rapid deployment of Sotto® sensors, South East Water plans to deploy advanced analytics to automate the process of leak detection and location. By training a machine-learning algorithm it also aims to understand leak profiles, to provide insights to operators and maintenance teams about the likely leak scenario, ahead of them attending sites to pin-point and fix leaks.
This is game-changing technology, supporting South East Water to deliver on its commitment to achieve sustainable value to customers, through improved services and lower costs over the long term, while protecting our precious water resources.
iotaservices.com.au
Before network leak repair After network leak repair
Presented by
INCREASE UPTIME







Reliable supply of automation systems - even during power failure - is required in many applications to avoid key data loss. The UPS system is designed to sustain the control system alive for a certain period of time, from a few minutes to several hours.






WAGO UNINTERRUPTIBLE POWER SUPPLIES ( UPS ) KIT







BENEFITS:
Space Saving
Only 115 mm width in total - Including the battery
Quick Onsite Installation
CAGE CLAMP® technology with plug-in connectors
Fuse Protected Battery

Short-circuit and reverse voltage protection


(03) 8791 6300

Power Supply with Integrated UPS Charger and Controller 24 VDC Lead-Acid AGM Battery 24 VDC 787-1675 5 A 787-1671 0.8 Ah 127 97 72 60 135.5 124.5
registered trademark
WAGO
mbH. Charge/ Battery Module, 787-876 Power Supply with Integrated UPS Charger and Controller, 787-1675 787-876 1.2 Ah Other Battery Sizes 787-871 3.2 Ah 787-872 7 Ah 787-873 12 Ah 136.5 175.5 217.5 217.5 55 76.2 86 120.5 153 168 236 236
sales.anz@wago.com | www.wago.com.au WAGO is a
of
Verwaltungsgesellschaft
Culture, collaboration and strategy
64

68 PARTNERING FOR INCLUSION
Water Corporation collaborates to support First Nations students.
56 BRIDGING THE SKILLS GAP
As the skills shortage continues to intensify, a lot is at stake for the future of water. What can the water community do to bridge the gap?
To discover more business news, visit awa.asn.au/news
 Q&A: MARLENE KANGA Dr Marlene Kanga discusses why intersectional diversity is crucial.
Q&A: MARLENE KANGA Dr Marlene Kanga discusses why intersectional diversity is crucial.
55 Australian Water Association
SKILLS GP A BRIDGING THE
By Martin Kovacs
The rapidly growing skills crisis is a key economic challenge faced nationally and by multiple sectors. It comes amid a surge in public infrastructure spending and project activity, with the water sector among those in this space dealing with increasingly pressing labour issues, as well as being on the
verge of generational change. How the water community navigates these issues will have a large bearing on how well positioned it is to tackle a host of challenges.

The National Skills Commission’s 2022 Skills Priority List revealed shortages in 286 occupations, almost double the 153 recorded in 2021. Putting this accelerated tightening of the labour market into context, the commission notes Australian Bureau of Statistics data shows
the unemployment rate fell to a 48-year low in July, while job advertisements jumped 42% year-on-year in August.


Meanwhile, Infrastructure Australia’s Infrastructure Market Capacity 2022 report, which puts the value of major public infrastructure projects at $237 billion over the next five years, found that as of October 2022 public infrastructure projects, including small-capital projects, faced a shortage of 214,000 skilled workers.





As the skills shortage continues to intensify, there’s a lot at stake for the future of water. What can the water community do to bridge the gap?
Discover more. awa.asn.au 56 Ozwater’23
The report projected labour demand will increase to a peak of 442,000 this year, more than double the projected available supply, and notes project slippage is to be expected as the market struggles to respond to “highly inflamed conditions”.






Aurecon Managing Director for Water Kevin Werksman said that, amid this wider infrastructure boom, the sector now finds itself at a critical point in its history as it strives to deliver efficient, reliable and sustainable services.
“The water sector’s experiencing the same supply-side gap as other industries,” Werksman said. “However, there’s an almost unprecedented set of major projects on the horizon, and that’s going to make it much harder for us to navigate workforce challenges.
“At the same time, we do have some advantages, in that people who tend to work in water have a real passion for the environment, sustainability and liveability, and most of them would prefer to continue working in our sector.”
KEY INVESTMENT DRIVERS

Against the broader backdrop of the infrastructure challenges

the sector is facing, it is also undergoing a significant transition in its underlying operational approach, with utilities increasingly harnessing digital technologies to deliver efficiency benefits.
This ongoing shift from a predominantly asset-centric focus to a digital-enabled, customer-first approach sees customer-derived insights not only being used to improve service offerings, but to also guide asset management and investment decisions.
As business models continue to evolve, and in weighing up the wider workforce impacts and skills that will be required, Werksman emphasised the importance of initially building an understanding of the sector’s key investment drivers.
“The first driver is very much around ageing assets, and how we best maintain our services in that space,” he said. “The next is around resilience, and how we respond to climate change and other threats.
“We’ve also got increased demands related to standards of living, standards of customer service, the greening of our cities, and what we discharge into waterways, and are facing drivers
There’s a role to become much more active in engaging outside of our sector, and engaging with the broader community, which will help attract a greater number of people.
Business 57 Australian Water Association
Kevin Werksman, Managing Director for Water, Aurecon
SWAWater istheworldleadingindustrial wastewatertreatmentcompany.Australian ownedandoperated,withofficesin Australia,MalaysiaandThailand,wedeliver completeturnkeyengineeringsolutionsand productsforwastewatertreatmentplants.

IndustrialWastewaterTreatment
SWAProducts
Oilseparators
DAFunits
Solidseparators
Clarifiersandthickeners
DAFthickeners
Screens
Beltfilters
Filterpresses
Greasearrestors
Siltarrestors
Biologicaltreatmentplants

Polymerblendingplants
Chemicalstorageplants
Electricalcontrolpanels
SWAServices
Design
Manufactureandsupplyof equipment



Installationworks
Turkey design andconstruct projects
Laboratorytestwork
Siteinvestigations
Pilotplanttrials
Serviceandmaintenance
IndustrialExperience
Miningindustry





Steelprocess
Oilrefineries
Petrochemicalplants

Powerstations
Powerstations
Foodindustries
Automotiverepairs
Desalinationplants
Beverage
Textile
Biodieselproduction
Icecream& Dairy
Electroplaters
SWAWaterhashundredsofplantsinoperation,spanning5continents.Someofourclientsinclude:
+61297730845
Ourexpertengineersarecommittedto innovatingend-userfocusedsolutionsthat meetexactspecifications. swawater.com.au
info@swawater.com.au

AD
TheLeadersin
around regional services versus metro services.”



In this increasingly varied investment landscape, the sector will need to continue exploring different approaches by necessity, with Werksman pointing to opportunities existing around smarter asset management and utilising digital tools to drive efficiencies.
Werksman also stressed the fundamental importance of assessing customer and community risk appetites towards climate change in sculpting an appropriate investment pipeline, alongside improving water literacy at a broader level.
“It starts with building a greater appreciation of those challenges, of why water is so important, and some of the technology, cultural and other barriers that need to be overcome to attain a sustainable water future,” Werksman said.
“I think there’s a role to become much more active in engaging outside of our sector, and engaging with the broader community, which will help attract a greater number of people into the sector.”
TRAINING TROUBLE

TasWater Program Manager PCC






Strategy Melissa Flynn pointed to the challenges TasWater and the sector more broadly is currently facing due to a lack of registered training organisations (RTOs) capable of delivering Certificate III and IV in Water Operations qualifications.





“From a purely water operations basis, we’re in a bit of a crisis nationally, in that there’s just not many RTOs delivering training,” Flynn said. “In the last two years, TasWater lost its major RTO, and subsequently another one, and we’re nationally down to two at the moment actually providing the qualification.”
In turn, this has led to TasWater exploring alternative methods to shore up its workforce, particularly considering the utility also faces the additional challenge of managing an extremely disparate, geographically diverse and aged infrastructure network.
Flynn explained that, with around 14% of TasWater’s workforce aged over 60, this includes its broader transition-to-retirement strategy, a key element of which is ensuring

There are lots of different heuristics we can use to understand the nuances of particular assets, drawn from the people who are on the ground, comprising hundreds of years of experience still within the business.
Business 59 Australian Water Association
Melissa Flynn, Program Manager PCC Strategy, TasWater
knowledge is passed on from employees nearing retirement.
“There are lots of different heuristics we can use to understand the nuances of particular assets, drawn from the people who are on the ground, comprising hundreds of years of experience still within the business,” she said.
“All of our plants are different and a lot of our infrastructure is very old. In many cases it comes down to understanding those little quirks, and we have experienced operators who know the assets inside and out.”
Flynn said TasWater is also prioritising flexibility in its employee value proposition (EVP), noting the Covid pandemic has changed community attitudes towards work-life balance at a broader level.
“We’re also shifting from the traditional mindset that you will sit in the one role, to looking at an individual in terms of what skill sets they actually have and how we can put that to work,” she said.
“At the same time, we’re moving in a direction where we’re breaking down the silos between the different business areas, and having a much better conversation around what our workforce will look like from a collaboration point of view.”
COMMUNITY-FIRST FOCUS
Greater Western Water (GWW) Chief People Officer Louise Meadows said the Victorian utility’s broader people and communityfirst focus is reflected in its 2030 Strategy, which includes “a clear statement of intent to have an adaptable, highly skilled and purpose-driven workforce”.

GWW oversees a wide-ranging training and development program for its technical workforce at its newly established Melton training centre, which Meadows said will become a central component of the utility’s Technical Training Academy.
“The academy will not only develop the future expertise we need, but also boost education and employment opportunities in our service region,” she said.
“It’s one of many initiatives that will deliver our 2030 Strategy, particularly how we support local communities to thrive.”
Meadows highlighted this year’s expansion of GWW’s graduate and trainee programs, along with work it has undertaken with the federal government initiative JobAccess to provide employment opportunities for candidates with accessibility requirements.

“We’re ensuring we’re attracting skills from the broadest talent pool possible,” she said.
“We know that employing a diverse range of people helps provide a better experience for our customers by reflecting the diverse communities we serve.
“We’re actively targeting more diverse talent that might not normally seek or secure employment in our sector. An example of this is our recent appointment of two visually impaired customer service consultants to our team.”
While GWW has proactively set about forming regional partnerships to achieve common economic goals, Meadows noted that, at a broader level, the sector
We’re actively targeting more diverse talent that might not normally seek or secure employment in our sector.
Louise Meadows, Chief People O cer, Greater Western Water
Discover
60 Ozwater’23
Hybrid study-work arrangements at a thermal lab.
more. awa.asn.au
has always worked incredibly well together to tackle a range of issues.
Meadows highlighted an industry-wide project she has been involved in, with the water sector working together to develop a broader value proposition to help attract and retain people to careers in water.
“By lifting the profile of the sector, we can make it more visible and compelling to the best people, and in turn improve attraction and retention rates,” she said.
“With the trend towards employees seeking work in purposeled organisations, we believe we can capitalise by highlighting the work the sector is undertaking in areas such as climate change, sustainability and public health.”
FINDING FLEXIBILITY
Amid projections of increased major construction and infrastructure investment growth in South East Queensland, Seqwater General Manager People, Culture and Safety
Melissa Williams noted resourcing for the organisation’s capital delivery program will remain a challenge in the coming years.
Williams said Seqwater’s Next Generation program, designed to grow talent in critical areas, will continue to be a key focus, with the utility welcoming applicant diversity, from school leavers to mid-career candidates seeking a career change, via its targeted traineeship approach.
“We offer traineeships in dam operations, water treatment, and recreation and catchment operations, and are exploring flexibility for trainees to switch between streams, if an employment opportunity is greater in another stream,” she said.
“We see this as a win-win, as a trainee could potentially complete the program with more than one qualification and secure ongoing employment with us, while we retain the talent aligned with our strategic workforce needs.”
BUILDING A BRIDGE: KEY STRATEGIES
NATURAL ADVANTAGES








People working in the sector are often motivated by a passion for the environment, sustainability and livability. Water businesses can promote these values when attracting talent.
INVESTMENT DRIVERS


Identifying key drivers can help pinpoint opportunities to streamline operations – for instance, via smarter asset management and utilising digital tools.
Beyond addressing the immediate challenges of the stretched labour market, Williams noted a strategic approach with a longer planning horizon will be essential to help meet future needs, particularly when it comes to developing skills in-house.
In addition to this, Seqwater’s ongoing standardisation of equipment is an important focus in minimising training requirements and laying the groundwork for workforce efficiencies that last well into the future.
“We have a comprehensive set of engineering standards that are applied across the asset base any time a project is undertaken,” Williams said.
“This results in a level of standardisation in the equipment as part of the normal deployment of sustaining capital investment, improving the ability for water treatment plant operators to work interchangeably across multiple different sites.”
COMMUNITY ENGAGEMENT
Highlighting and building an appreciation of the work the sector is undertaking in areas such as climate change, sustainability and public health.
EMPLOYEE FLEXIBILITY
Prioritising training flexibility and looking at how individual employee skill sets can be applied across multiple roles.
Business 61 Australian Water Association
Seqwater will continue to work collaboratively with other water entities in addressing labour challenges across the whole sector, while also maintaining close relationships with training providers.


Williams emphasised the importance of focusing on the natural advantages the sector has in undertaking employment initiatives that highlight water’s value.
“As reflected through our research, there is a real sense of pride in the fact that we deliver safe, sustainable and valued water supply to the people of South East Queensland,” she said.

“Highlighting this as part of our employer branding focus, along with the rewarding career choices available within the sector and Seqwater, remains crucial in attracting and retaining the right talent.”
Borehole Pumps


Are submersible water pumps can be operated while completely submerged underwater, there is many useful applications, but the typical use is to pump water from a certain source, such as a water well, to a different desired destination.
VR Series
Vertical multi-stage pumps are available in high- and low-speed models for superior durability, efficiency, and performance in a wide variety of applications.

FPS ISO Series

Designed for both industrial and agricultural application.

Submersible Motor
Franklin's full line of submersible motors can be used for groundwater and other submerged pressure pumping applications. Our motors are tough, built to last, and come in a variety of options.
Moving Water Moving Forward
Discover more. awa.asn.au
“The AWA is the best forum for anyone in Australia wishing to connect with water issues as professionals or just people with an interest in water.”



















The benefits of being a professional member of
Elevate your profile Access discounts Exclusive content Awards program Private jobs board Specialist networks
Q & A DEEPENING DIVERSITY & INCLUSION WITH AN INTERSECTIONAL MINDSET
Diversity and inclusion objectives often focus on race and gender, but non-executive director and leading diversity advocate Dr Marlene Kanga AO says it’s time to reach further to get intersectional diversity done right.
 By Cecilia Harris
By Cecilia Harris
What does intersectional diversity mean to you?
The term “intersectionality” has been around for some time. I understand that the term was coined about 30 years ago to describe the impact of discrimination due to race and gender, and the negative multiplier impact of the intersection of both of these two factors.
HIGHLIGHTS TARGET: Increase the number of women and people of diverse backgrounds in STEM fields.
METHOD: Promoting increased awareness of unconscious bias, as well as strategies for inclusive workplaces.
Today the definition seems to include all aspects of our diversity, including broad definitions of gender, ethnicity, age, physical and mental characteristics and abilities, religion, policies and socioeconomic status.
Tell us about your experience as an engineer so far. Has your lived experience informed your thoughts on the importance of intersectional diversity?
I have had a long career in engineering and was among the first few women to graduate in chemical engineering from the Indian Institute of Technology Bombay, India’s leading engineering institution. I was also among the first few women to study chemical engineering at Imperial College London, another world-leading university. In Australia, I was among the first few women to become a member of Engineers
Australia. It took me a long time to realise that I was at the leading edge of change that was needed for engineering and technologybased organisations to become more inclusive. Far from being welcomed, I had to prove myself every time, be at the top of my class and do outstanding work.
Today the importance of diversity and inclusion, especially in engineering organisations, including the water sector, is well recognised. There is a talent war to hire more women and First Nations people.
However, organisations need to go beyond binary definitions of gender and embrace the wide diversity in the population so that everyone can come to work as themselves and be the best they can be.
It sounds simple and obvious. Yet barriers remain, some subconscious, even from those who advocate for diversity and inclusion.
In my own career, I have enormous capacity that has never been fully used. I have spent more time and energy battling the barriers than being able to contribute. At least I remained in the profession.
Many have left, especially women, due to a difficult workplace culture, which is a huge loss to our country and our sector.
Discover more. awa.asn.au 64 Ozwater'23
When I first arrived in Australia, I applied for hundreds of jobs that were advertised under “Men and Boys” in the newspapers. Most people had never seen a woman engineer, let alone a migrant engineer. I had set my heart on a job in a consulting company that did the kind of work that I had specialised in at Imperial College.
However, I was unsuccessful, and I was devastated. It took me many years to realise that I was not the issue; the organisation had never hired a woman engineer before. It’s very telling that eventually my first engineering role in Australia was with a large US multinational company.

I was only the second woman engineer they had ever hired. Clearly, they had more progressive views than local companies. My American boss even informed me that I “ticked two boxes” in the company’s diversity objectives.







The point is that the barriers are systemic. Many take the setbacks they face as being their fault, but it is not. I have made this point at presentations around the world, and each time it’s a eureka moment for the audience.

When there is the realisation that there is a systemic issue – and unfortunately this exists around the world – people feel empowered and more resilient.
Why is it important for the water community to broaden its diversity lens to consider diversity beyond gender?
All organisations must broaden their diversity lens, especially in the water industry, where we are privileged to serve the community, providing a basic service that is a human right. It’s therefore important that water organisations have teams that reflect the community that is being

served – in terms of age, ethnicity, gender and so on. Ensuring deeper levels of intersectional diversity within organisations enables a better understanding of community issues. For example, resistance to drinking tap water or paying higher costs for improved service availability.
What are some of the benefits that come from ensuring teams and workplaces are genuinely inclusive?
The benefits of diverse teams are significant. Employees in inclusive organisations will feel safe and comfortable, will thrive and be the best they can be.


Retention levels will be higher and there will be high levels of engagement with the organisation’s strategy and vision. Higher retention levels will lead to reduced recruitment costs and training efforts. The organisation will make the best use of all human resources and will be a happier place.
Diverse teams will also develop more sustainable and innovative solutions because they will understand and reflect community and stakeholder values and



expectations. Diverse teams encourage innovation and new ideas, reduce risk, enable better decision-making and avoid ‘group think’ because all aspects of a proposed solution or development are considered.

Importantly, an organisation that has open, transparent and systematic approaches to recruitment, performance assessment and advancement will also have a strong ethical culture and good governance. There is considerable research that shows that diversity enhances business performance, improving financial performance, reducing earnings volatility, improving customer relationships, safety and environmental performance. All this also enhances reputation. The organisation will be an employer of choice and will attract the best people for all its roles.

65 Australian Water Association
Images
Kanga attends a recent tour of the Bondi Treatment Plant
supplied by NSW State Archives
How do we get intersectional diversity right? What does it look like in practice?
We should create an inclusive organisation that welcomes everyone who can do the job. I developed a strategy for equity inclusion and diversity in 2014, and the principles are very relevant today. The strategy is based on the approach used to achieve cultural change in addressing safety in the organisation. The cultural shift has been significant, from “she’ll be right” and a lax approach in the 1980s, to wearing PPE and following safety procedures. This is now transformed into safety compliance being a non-negotiable requirement in engineering workplaces.
The same principles should apply to ensure that we have an inclusive culture that enables the widest diversity of employees to flourish. The strategy has been used successfully in large organisations in the utilities and transport sector where I have been a board member. It has also been used by the consulting engineering firms in the Consult Australia Champions of Change [network], where the strategy was launched in 2015. Seven of these companies are now listed as employers of choice by the Workplace Gender Equity Agency, compared with just two in 2015.
Just as with safety, visible leadership is important. the board and senior management need to publicly support policies on diversity and inclusion, and







model the right behaviours. Systematic approaches are essential to ensure inclusive recruitment, training and development, performance appraisals and advancement, and ensure pay equity for people who are doing the same roles. There is a need to change the language in job advertisements, target diverse applicants outside the organisation, increase awareness of unconscious bias, redesign jobs and facilities to be inclusive, and provide career development and preparation for leadership roles for a diversity of employees.
The board can also request reporting, especially of leading indicators on progress being made with the organisation’s diversity journey, just as with











safety. These indicators could include, for example, the percentages of different diverse groups at recruitment and various levels in the organisation to senior management, the percentages being trained, the tenure of staff at various levels, the difference in pay equity and statistics on those leaving the organisation.

Management training is needed to enable a collective understanding of the culture and values of the organisation and informed leadership, which will enable alignment with the organisation’s vision and purpose. Developing a diverse and truly inclusive organisation should be a strategic objective. The consequences will be a positive multiplier impact. Everyone will win.
Dr Marlene Kanga AO is a non-executive director of Air Services Australia, Endeavour Energy, Standards Australia and BESydney, as well as other boards involving innovation and the commercialisation of new technologies. Kanga was a non-executive director of Sydney Water Corporation, and is Chair of the Institution of Chemical Engineers (UK) global Safety Centre and Co-Chair of the Australian Government $41 million Elevate program run by the Australian Academy of Technology and Engineering to increase the number of women in STEM in Australia.
Discover more. awa.asn.au 66 Ozwater'23
“
I have enormous capacity that has never been fully used. I have spent more time and energy battling the barriers than being able to contribute.
Kanga onsite at Sydney Water’s wastewater treatment plant.


TheIoTplatform,fit-for-water iotaservices.com.au
CASE STUDY #2
PARTNERING FOR DIVERSITY
PROJECT: Deadly Sista Girlz partnership
REGION: WA
STARTED: 2022
LEADER: Waalitj Foundation
Water Corporation’s support for the Waalitj Foundation’s Deadly Sista Girlz program has created a valuable platform for ongoing community engagement and workplace diversity.
 By Martin Kovacs
By Martin Kovacs
Commencing in mid2022, the Deadly Sista Girlz (DSG) partnership ties in with Water Corporation’s broader focus on creating greater employment opportunities for Aboriginal and Torres Strait Islander people, supporting young women into STEM and closing the gender pay gap.
Water Corporation General Manager of People and Safety
Sarah Bagshawe said the utility is committed to running culturally appropriate and supportive recruitment processes, with the goal of building a workforce as diverse as the community it serves.
The Waalitj Foundation advises that the DSG program, delivered by strong Aboriginal and Torres Strait Islander role models, aims “to
Mentors and Water Corporation staff.
Discover more. awa.asn.au 68 Ozwater’23
Images supplied by Waalitj Foundation
improve engagement and education among school-aged Aboriginal and Torres Strait Islander girls”.
With a key focus on building selfesteem, confidence and pride in Aboriginal and Torres Strait Islander identity, the DSG program has been in operation since 2007, and is being run at 18 sites nationally, providing mentoring for over 1000 girls.
“The Waalitj Foundation is a well-known and respected WA organisation that supports education, employment and business opportunities for Aboriginal and Torres Strait Islander people,” Bagshawe said.
“Partnering with the Waalitj Foundation’s DSG program allows us to engage with young, aspiring women, build relationships and share the breadth of career opportunities that exist at Water Corporation.”
UNIQUE EMPLOYMENT OPPORTUNITIES
Since the partnership began last year, Water Corporation has had a presence at many DSG events, including its career expo, where program participants were able to learn about career opportunities at Water Corporation.
The expo saw Water Corporation engage with over 70 female students from across the state, educating program participants about job opportunities, while the utility has also supported resume workshops and shared knowledge about its recruitment processes.
In addition to this, it has held roundtable discussions with the Waalitj Foundation, focusing on how it can better attract, develop and retain Aboriginal and Torres Strait Islander employees.
“As one of the largest and most geographically dispersed employers

in the state, we are able to provide unique opportunities for Aboriginal and Torres Strait Islander people to work, live and remain on Country and connected to important community networks,” Bagshawe said.
“We support Aboriginal employees through the recruitment process, where they are coached through interview preparation. Once recruited, employees have access to workplace and career support through our dedicated Aboriginal Employment and Development team.”
For DSG alumna and Water Corporation Quality Assurance trainee Ellouise, the DSG program helped her develop the skills required to grow at a professional level, which she has put to use in pursuing a career in the water sector.
Ellouise, who first started with the program in primary school, said DSG has “always supported me in
making the right decisions for me. The program helped me develop my confidence in speaking to people I didn’t know so well”.
“This has helped me greatly in my current role, where I need to talk to our contractors, investigate incidents, provide technical support, attend inspections and much more.
“Water Corporation supported me in a Cert IV in Work Health & Safety and has continuously backed my study. I really enjoy my role because it has given me the flexibility to do a variety of work, which is all relevant to my passion and studies in work, health and safety.”
SUPPORTING DIVERSE WORKPLACES
Bagshawe said Water Corporation’s third Reconciliation Action Plan (RAP) is currently under development and designed to provide “clear targets and actions to drive positive outcomes for Aboriginal employees and communities”.
The RAP complements Water Corporation’s Yesterday, Today, Tomorrow Aboriginal engagement strategy, which commits to a range of objectives that seek to maintain an environment with a strong emphasis on collaboration and diversity.
“Developed by Aboriginal employees, Yesterday, Today, Tomorrow is our commitment to ensuring Aboriginal culture informs decision-making, while also acknowledging and healing from the past, to improve the equity of water services,” Bagshawe said.
“Reflecting the community we serve is incredibly important to Water Corporation. We aim to provide a culture where everyone feels they are valued, welcomed and belong. This is an ongoing focus and one we are committed to.”
A workforce that represents our wider community ensures we have diversity of thought and experience when making decisions and undertaking projects.
Business 69 Australian Water Association
Sarah Bagshawe, General Manager, People & Safety, Water Corporation
CASE STUDY #2
SUPPORTING FIRST NATIONS BUSINESSES
As well as partnering for diversity, in 2021-22 Water Corporation achieved the following results in Aboriginal business engagement.
145
% %
increase in value of contracts awarded to Aboriginal suppliers of contracts above
Supporting this broader approach towards education, understanding and improving cultural competency, all of Water Corporation’s employees are required to undertake Aboriginal cultural awareness training.
Bagshawe said this is not only designed to provide a deeper understanding of Aboriginal history, but also helps employees develop sensitivity to cultural differences and to better engage with Aboriginal decision-makers.
“Cultural competence is knowledge, behaviours, attitudes, policies and systems that enable service providers and workers to work effectively in cross-cultural situations and respond to the needs of a culturally diverse population,” she said.
“A workforce that represents our wider community ensures we have diversity of thought and experience when making decisions and undertaking projects. This allows us to be innovative in our thinking, planning, decision-making and service to the people of Western Australia.”
CLOSING THE PAY GAP
Over the last seven years, Water Corporation has made big progress in driving down its overall gender pay gap, which fell from 11.2% in 2015 to 4.7% last year, sitting well below state and national averages.
Moving forward, Water Corporation is committed to both refining its existing gender equity initiatives and introducing new ones in order to continue improving gender representation across all of the organisation’s various operations.
Established in late-2021, its internal employee network Gender Balance for Better has been advocating for gender equity, raising awareness among colleagues and undertaking initiatives such as educational workshops.
Bagshawe said Water Corporation has set about improving female management representation, with it investing in female development and leadership opportunities, while workplace flexibility is also a priority.

$50 , 000
awarded to Aboriginal companies
232
registered Aboriginal suppliers
5.1 $34.5
Value of contracts more than doubled to million compared to 2020-21
Source: Water Corporation
“Flexible workplace practices provide opportunities for all employees to find a healthy worklife balance while progressing their career,” she said.
“This includes offering workingfrom-home arrangements, compressed weeks and part-time hours, along with a focus on mental health and belonging in the workplace, helping to position Water Corporation as a familyfriendly employer.”
Discover more.
70 Ozwater’23
awa.asn.au
Don’t lose revenue to a leaky pipe.

Leaks cost more than just water. Plugthem with analytics and software that deliver data in near real time to detect leaks, reduce losses and protect revenue. Itron’s Water Operations Management solution provides insights into the overall health of your system—so you can say goodbye to leaky bottom lines.

More intelligence. More possibilities.
Itron.com/possibilities
© Copyright 2022 Itron. All rights reserved. Itron and the Itron logo are registered trademarks of Itron, Inc.


Keeping a firm eye on water quality
SOLVING THE COMPLEXITIES OF RELIABLE WATER QUALITY MONITORING WITH PRE-FABRICATED PANEL SOLUTIONS
A water quality measurement point typically contains a sensor, cable, flow through assembly and transmitter. In large water or wastewater projects, dozens of these combinations can be delivered to site. It can be a Herculean task to match these combinations together and install to produce reliable water quality data.
At the outlet of a water treatment plant, you may be required to monitor both turbidity and disinfection at the same location. The low turbidity measurement may require a de-bubbling type system, whilst the disinfection point needs an inline filter to reduce buildup in the probes and assembly. If you install the filter before the turbidity assembly, your measurement result becomes inaccurate since solids contributing to turbidity are removed. If you forget to install an inline filter before the disinfection probes, the excessive build-up will increase maintenance intervals. What’s more, space is often at a premium at the intended measurement point location, and there’s no chance to install elsewhere. Combining multiple analysis parameters into a small location whilst complying with all of the intended installation conditions can be an enormous challenge.
It’s easy to see that some expertise and considerable engineering time are required to ensure water quality monitoring installations are correct.
What is a panel solution?

A panel (or instrument panel) is a plate made of either plastic or stainless steel on which one or more measurement points are pre-assembled. The plate is secured onto a wall or a frame/rack from which sample lines are distributed. Ideally measurement points should be able to be virtually managed and come delivered with all components included, helping you to drastically minimise engineering, installation and commissioning time.
Where can I use panel solutions?
Analytical panel solutions can be used for many applications in both water and wastewater networks. A typical panel solution may involve monitoring ammonium, pH, and free chlorine for environmental compliance at the effluent of a wastewater treatment plant. Alternatively, panels may be required for monitoring water quality from a bore extraction process. Be it high process pressure, multiple measurement parameters, or restrictions in available space for installation, there is an option to construct customised panel solutions to match your specifications.
Safe and future-proof.
Panel solutions designed by Endress+Hauser incorporate a unique modular concept to help you get from conceptual development to implementation and commissioning quickly. All you need to do is connect the sample inlet/outlet, and you are up and running. Panels are delivered ready for installation with all components for sample preparation and communication to your higher-level systems included. Furthermore, Endress+Hauser provides a local support network to partner with you throughout your panel’s entire life cycle.
Overcoming challenges with ease.
Analytical panel solutions can benefit your projects in many ways. Since the panels are supplied with all assemblies, cables and sensors pre-mounted, commissioning is easy. There’s no more worrying about each measurement parameter’s specific characteristics since the panels are all optimally designed with this in mind. Panels are repeatable in quality and dimensions so that they can be easily specified for small or large projects. Fully traceable documentation (including factory commissioning tests) is supplied as standard, which can be included in your handover process. Sensors contain Memosens® plug-and-play for simple probe maintenance and Heartbeat® technology to verify the entire measurement point. When you’re ready to integrate into your existing control system, select from a large variety of communications protocols (HART, PROFIBUS DP, EtherNet/IP etc.).
Save time, increase reliability.
Water treatment processes depend on reliable, hassle-free water quality monitoring to ensure environmental compliance. Save time and take advantage of Endress+Hauser’s range of panel solutions in your next project.
 Luc Turner is the Water & Wastewater Industry Manager at Endress+Hauser Australia.
Luc Turner - Endress+Hauser Australia
Luc Turner is the Water & Wastewater Industry Manager at Endress+Hauser Australia.
Luc Turner - Endress+Hauser Australia
Compact solutions for water quality monitoring
Plug and play analytical panels for all your measurement tasks



Want to monitor water quality with minimum engineering time and maximum reliability? Check out our water analysis panels offering plug and play installation, state-of-the art instrumentation and complete customisation to your exact needs.


•Compact designs: reduced footprint for space saving installation




•Panel modularity: systems can be flexibly extended
•Plug and play: commission panels faster than ever before

•Multi-parameter: more monitoring options, reduced cost

•Standardised: reduced engineering effort for small or large projects
•Multiple communication options: seamless integration regardless of site standards


www.au.endress.com Download info
Climate solutions

Freshwater accounts for only 2.5% of water across the globe. Factors such as global warning, rapid population growth and urbanisation will significantly affect Australia’s ability to maintain a reliable water supply. A ticking climate clock, ageing infrastructure and rising customer expectations means water technologies, treatment infrastructure and networks will play an essential role in preserving public health, social justice, food supplies, regional resilience, and resources.
Strengthening Australia’s water supply is a key step towards sustainability and combating climate change. Veolia understands the challenges faced by industry, municipalities and water authorities around the world.


Veolia strives to support water authorities and businesses, increase operational efficiency, and improve customer service, while delivering value across all stages of the water cycle. Veolia looks after all aspects of resources and assessment management – including the production and delivery of drinking water, industrial process water collection and the treatment and recycling of wastewater and its by-products.
Veolia’s wastewater recycling and reuse services are designed to help reduce the impacts of climate change. To service the water refining, filtration and disinfection needs of its customers worldwide, Veolia uses 350 internationally tested and proven technologies. Our plan is to help clients select, manage and operate the source of water that best meets their needs. These supplies include
alternatives which can be relied upon, even during severe weather events. Recycling, for example, provides users with a solution that is climate independent, and more economically viable and environmentally sustainable than desalination due to reduced operating costs and energy consumption. Wastewater, recycling and reuse activities are central to the ecological transformation that is vital if we are to move to lower carbon lifestyles.
Veolia’s resolute commitment to ecological transformation means we can respond to the highly complex equations that condition tomorrow’s world. We have adapted our business activities in water, energy and waste management so we can better support our stakeholders in their own transformations. The goal is for everyone to join forces to tackle these challenges, while also preserving natural resources and tackling the climate emergency.
Advertorial
Scan the QR code to learn more about how these activities actively contribute to building a more sustainable future and how Veolia leverages innovation to roll out new solutions for tomorrow.
Resourcing the world with sustainable water management
76 EQUITABLE TRANSITIONS











Big transitions come with a heightened risk of inequality, and Australia must come to terms with the socially uneven distribution of risks and benefits involved in the transition to decarbonisation.








Health, research and social justice To discover more community news, visit awa.asn.au/news 82 WATER FOR LIFE How Purple House is changing lives by providing dialysis services on Country. 86 INDIGENOUS RESEARCH METHODOLOGIES Applying Traditional Knowledge for sustainable water management. 75
EQUITABLE TRANSITIONS












76 Discover more. awa.asn.au Ozwater’23
By Cole Latimer
The world is undergoing one of the greatest energy transitions since the start of the industrial age as we continue to move from coal and fossil fuels to clean energy.
And a major part of this shift from traditional energy sources to lower-emissions energy, like renewables and hydrogen, is also the goal for many countries to reach net-zero emissions by 2050.
As this transition progresses, many have raised concerns that developed countries have done little to help ensure a sustainable transition for all, which will only worsen global poverty and people’s lack of access to resources such as water or energy itself.
“Demands for net-zero emissions for all countries by 2050 will exacerbate further the existing inequities between developed and developing countries,” a conglomeration of developing countries stated during COP26. They dubbed calls for all countries to meet net-zero emissions by 2050 “antiequity and against climate justice”.
The net-zero transition will change how and where water is used for energy generation, from cracking water through electrolysis for hydrogen creation, in crucial battery manufacturing, diverting or holding back for hydroelectricity, or via energy recovery from anaerobic digestion of wastewater. With water being used elsewhere in new and different processes as
part of decarbonisation efforts, it could mean not all people will retain the same access to water, thereby introducing or perpetuating divisions. But, with the right steps, could the water community’s energy transition avoid introducing or deepening inequalities?
NET-ZERO WATER
A recent report by Australia’s Monash University and the Royal Holloway University of London, titled Just Transitions, highlighted that Australia is yet to come to terms with the full future impacts of an energy transition. It examined how a nation could shape decarbonisation in a way that is both “ecologically sound and socially just”.
The study called the transformation a complex development, noting a just transition could not simply follow a recipe for success due to Australia’s unique challenges, adding “the conversation has become controversial to the point where even talking about ‘just transitions’ can be critically received”.
The study said an approach needs to put people as well as the environment at the forefront of this change, but what does this look like when it comes to water usage, access and conservation during the energy transition?
Lisa Zembrodt, Principal and Senior Director of Schneider Electric’s Sustainability Business, painted a worrying picture of uneven access to water and potential scarcity if the energy transition is not carried out with total sustainability.

“The energy transition will increase
demand for water. When it comes to any transition involving natural resources, we must always consider equity, and a whole-of-system approach is needed from the planning stage,” Zembrodt said.
“To be sustainable, it’s essential we consider not just the carbon impact, but the water impact, as the two are linked, and efficiency of one cannot be achieved without increased efficiency of the other.”
Zembrodt said a whole-ofsystem approach is critical to ensure enough water is available for people and processes. “Water scarcity and access will only become more complicated as the energy transition accelerates,” she said, adding that it shouldn’t slow the transition and global decarbonisation, as climate change itself is already accelerating water scarcity issues.
“There must be enough usable water available to support all the activities we aim to undertake.
Zembrodt said a net-zero water approach that only allows development projects to go
Big transitions come with a heightened risk of inequality. Australia must come to terms with the socially uneven distribution of risks and benefits involved in the transition to decarbonisation.
When it comes to any transition involving natural resources, we must always consider equity and a wholeof-system approach is needed from the planning stage…
Community 77 Australian Water Association
Lisa Zembrodt, Principal and Senior Director of Sustainability, Schneider Electric
ahead if they have a cumulative net-zero impact on water is one way to reduce the risk of negative outcomes for end-users at a consumer and industrial level, and for water suppliers during this transition phase.
“Corporations are already feeling pressure from investors and society to improve their water strategies, and collaboration and partnerships are key to solving these problems,” she said.
“Water users should also be looking to understand their current water usage and long-term needs, set a sustainable water strategy, and make progress towards targets to achieve the strategy in terms of resilience, security, waste, pollution and ecosystem impact.”
Using improved water sourcing practices, localised treatment and water-use optimisation techniques can also help reduce the risk of running out of usable water.
In terms of the role water utilities are able to play in socially and environmentally equitable transitions to net zero, Urban Utilities Futures Specialist Glen Taylor said the growing demand

TRANSITIONING TO






































due to increasing populations adds an extra challenge – and one that must be addressed now.
“As Queensland’s largest water service provider, we have a direct impact on many important issues like water security, liveability, circular economy, biodiversity, water cycle changes and other key community challenges. The decisions we make today set us up for the future we want to have,” he said. “Our communities trust us to do the right thing by them, and achieving net zero in a clear, costeffective and efficient way is the right thing to do.
way to ensure we maximise benefits for customers, environment and community.”
Included in Urban Utilities’ net-zero roadmap is a continued dedication to improving energy efficiency, increasing renewable energy generation on site, investing in local offset projects and including recycled water in the supply mix. Despite increasing populations, Taylor said, water and wastewater service providers are well positioned to tackle net-zero equitably by embracing the circular economy, while keeping customers and the environment front of mind.
“Our net-zero roadmap outlines the path we’ll take to reduce our greenhouse gas emissions and embrace 100% renewable energy in the most effective, cost-efficient
BEST-PRACTICE PRINCIPLES
6 5 4 3 2 1


“As a water utility, we’re in a unique position in that we can produce our own renewable power through wastewater treatment,” he said. Lean
Hone in on inclusive storytelling, raising awareness of the crucial need for just and equitable progress .

into improving water-sourcing practices, localised treatment and water-use optimisation techniques.
EQUALITY:
The decisions we make today set us up for the future we want to have.
78 Discover more. awa.asn.au Ozwater’23
people and the environment come first.
a whole-ofsystem, net-zero water approach, ensuring activities and projects keep a close eye on water use, and not just reducing carbon emissions.
into water-sourcing
into technologies and software to improve water e ciency, climate resilience and sustainability.
Glen Taylor, Futures Specialist, Urban Utilities
ensuring
Take
Lean
Tap
Assess the benefits and costs of all net-zero initiatives to di erent members of the community.
“Renewable energy isn’t the only valuable resource being created through the treatment process; we’re also supplying recycled water from key wastewater treatment plants to help increase water security for customers. Recycled water supports a circular economy to ensure we get more than one use out of precious resources.”

SYSTEMS OF CHANGE

To ensure communities are not left worse off, the concept of a ‘just transition’ must be explored, Australian National University Institute of Water Futures Associate Professor Katherine Daniell said, especially when it comes to water.
“All transitions have the potential to change the structure of society and thus to either deepen or lessen

Community
inequality. If the energy transition isn’t designed and governed effectively, then we can see that certain inequalities will play out, including between genders, urban and rural, high and low socioeconomic status, and even those who have access to natural resources or not,” she said.
When it comes to water, society’s strong focus on decarbonisation could cause an imbalance in the transition that puts resources like water at risk.
“We need to go beyond just focusing on carbon and technologies, and think about the broader social and environmental systems these are embedded in, including our surface and groundwater systems, people in communities, what indicators and values they care about, and how these transitions might play out for them,” Daniell said.
“If society overly focuses on one indicator for the environment, like carbon, we risk downplaying other key indicators of environmental and societal health and wellbeing, such as water use, as well as potentially creating other damage or unintended consequences through particular choices of energy production.”
Daniell said each energy system uses water differently and requires different resources.
“Such as minerals for batteries,




cement for dams, water for cooling or energy system production. These things will impact water systems differently through pollution or benefits”.
Daniell said there is no single solution to mitigating these risks, and with any major change there will always be trade-offs, but support for a just transition rests in part on being both socially and politically important. The focus is currently on decarbonisation to the disservice of other factors.
“We are far from a pandemiclevel global response to working together,” she said.
“And much of that is likely to do with people currently feeling like the costs and gains will be too unevenly distributed, and interests in specific indicators and technologies don’t positively capture their imaginations and their will to change.
“We’re going to need engaging and inclusive stories, not just data, to move the world forward.”
While the world continues to tread a new path in the energy transition, a comprehensive resource-usage point of view must be taken.
And in the search for net-zero emissions, a net-zero water loss approach must also be considered to ensure that a sustainable transition occurs that can benefit all people equally.
COMPOUNDING PRESSURES


Clean energy resources, particularly green hydrogen, can be water intensive, increasing the competing demand for water.

Focus on carbon reduction alone overlooks growing water scarcity issues.
Ine ective design and governance of energy transitions will lead to inequalities between genders, urban and rural communities, and high and low socioeconomic status.
If society overly focuses on one indicator for the environment, like carbon, we risk downplaying other key indicators of environmental and societal health and wellbeing, such as water use…
80 Discover more.
Ozwater’23
Associate Professor Katherine Daniell, Institute of Water Futures, Australian National University
awa.asn.au



in supporting the delivery of water to the world’s poorest people while improving your own company’s productivity? WaterAid can help drive your business, your staff productivity and
in
WaterAid transforms lives by improving access to safe water, sanitation and hygiene in the world’s poorest communities. Partner with WaterAid on a state, national or global level to benefit your business and improve lives. Memberships and sponsorships are available. Call 1300 858 022 Email info@wateraid.org.au Visit www.wateraid.org/au
Interested
support those truly
need.
WaterAid / Tom Greenwood
It all starts with water
HEALTHCARE ON COUNTRY



Receiving healthcare on Country is crucial to keeping communities together, but the water required isn’t always available. One initiative is trying to change that, highlighting just how much progress is possible. how much progress is possible.







 By Elle Hardy
By Elle Hardy


82 Discover more. awa.asn.au Ozwater’23
At last year’s AWA/ WSAA Voices for the Bush Conference in Alice Springs, National Aboriginal Community Controlled Health Organisation CEO Patricia Turner AM laid down the gauntlet to improve remote water access.

“The National Agreement [on Closing the Gap] signed in 2020 has a 10-year timeframe, and we are already two years in,” she said. “Few of the 17 targets are on track to meet their trajectories and some have worsened over time. These targets will neither move quickly, nor in the right direction, until all the structural impediments are dealt with.”
One area where poor water quality is coming into sharp focus is healthcare on Country, where it can have devastating impacts on the health outcomes and quality of life for Aboriginal people.
Purple House, a non-profit health service, owned by First Peoples, providing dialysis treatment in the most remote parts of Australia, is showcasing how innovative approaches to water provision for healthcare can help close the healthcare gap.
Irene Nangala is Chair of Purple House and a dialysis patient from Kintore, a remote Northern Territory community some 600 kilometres west of Alice Springs and 40 kilometres from the border of Western Australia. Nangala said breaking up family and community inspired her to push for dialysis treatment in her community.

‘‘I used to see my sister and brother in renal dialysis. They never returned back home to Kintore,” she said. “We took our old people to go back home because we missed them. Our old people say, ‘We want to go back, we belong to that Country.’”
Nangala has been part of the Purple House from the beginning – but didn’t know she would wind up needing treatment herself.
Since starting dialysis in 2013, she has been able to spend her time between Kintore and Alice Springs, advocating for better services for her community as the Central Australian representative on Kidney Health Australia’s national consumer group.
“Because of Purple House, we get to see our grandchildren grow up,” she said. “We can stay strong and share our stories and our culture, and our families don’t have to worry.”
Having experienced the benefits of the program first-hand, Nangala is now helping it spread to service other remote communities.
The benefits are already proving profound, with research from Menzies School of Health Research showing that when people are home on Country for dialysis with family and community, they have fewer hospitalisations and medivacs, a longer life expectancy and better quality of life. For Nangala, that also means simple pleasures such as sleeping outside and smelling the fresh air.
“Sometimes I go and sit with my young sister and go around to my family, sit down and have a little story with them,” she said.
“[It makes] me happy and feel good. I like to go back for singalong. I miss them. I miss going hunting for goannas too, hunting and getting some bush tucker.”
Because of Purple House, we get to see our grandchildren grow up. We can stay strong and share our stories and our culture, and our families don’t have to worry.
Irene Nangala, Chair, Purple House
Community 83 Australian Water Association
The Purple House truck at Uluru.
FROM WORST TO BEST
Sarah Brown AM was Purple House’s first employee and recently celebrated 20 years as its CEO. Brown said the organisation was founded by Aboriginal leaders who wanted to start a communitycontrolled health service to get their people home and into culturally appropriate care.
‘‘In the 1990’s there was an alarming rise in the number of Aboriginal people with advanced chronic kidney disease who were permanently forced into town for dialysis treatment three times a week,” she said. “They lived on the fringes – on someone else’s Country – disconnected from all that was important to them. It led to poor physical and mental health outcomes for patients.”
Elders were also missing from communities where they were needed to pass on Cultural Knowledge and provide leadership, which fractured families and social cohesion in communities.
‘‘A lack of water security and water quality has a profound impact on people’s capacity to stay well and hydrated,” Brown said. “When this is compromised, people’s kidneys won’t stay healthy and they’ll be at greater risk of

kidney disease. It’s also tough to expect people to choose water over soft drink when it tastes terrible, is poor quality and, in numerous remote communities, is inconsistently available. Those issues are also a major barrier to providing remote dialysis services since each treatment requires significant amounts of high-quality water.’’
Brown said Purple House’s unique model and constant innovation has helped improve health outcomes for dialysis patients in Central Australia, going from the worst to the best nationally.
‘‘Indigenous patients here are living longer on dialysis than the average non-Indigenous person in a metro city on the east coast,” she said.
The effects on community and culture are equally extraordinary.
Elders are able to pass on critical knowledge about culture that would otherwise be lost.
‘‘In 2013, we took the Purple Truck, our mobile dialysis unit, to Mutijulu so the late Mr Nipper could go home for a visit,” Brown said. “While he was there, he got to go out with rangers – in a helicopter, no less – to rediscover lost water holes that he had visited as a child. The rangers had heard stories, but had never been able to find them.”

A LONG WAY TO GO
Northern Territory Senator Malarndirri McCarthy said having access to good healthcare and services on Country is paramount to the health and wellbeing of Aboriginal people.
“Being away from Country can have physical, social and economic impacts on many remote First
HOW IS AUSTRALIA REALLY TRACKING ON SDG6?
Although the United Nations 2021 Sustainable Development Report indicates that Australia has achieved Sustainable Development Goal (SDG) target 6.1, a recent report* from Australian National University researchers shows Australia’s national reporting of drinking water quality is not fit-for-purpose, with national water quality statistics not inclusive of service providers with less than 10,000 connections.
“This means approximately two million people, or about 8% of Australia’s





population, are not included in reporting on the ‘clean water for all’ goal of the United Nations Sustainable Development Goals,” lead researcher Dr Paul Wyrwoll said.
The reality is that Australians in more than 400 remote or regional communities lack access to good-quality drinking water, and at least 25,245 people across 99 locations with populations of fewer than 1000 people accessed water services that did not comply with the health-based guideline values at least once in 2018-19.
Children visit family in treatment.
84 Discover more. awa.asn.au Ozwater’23
*Wyrwoll, P.R., Manero, A., Taylor, K.S. et al. Measuring the gaps in drinking water quality and policy across regional and remote Australia. npj Clean Water 5, 32 (2022).
Nations people who can spend extended periods of time away from Country, family and community,” she said. “Purple House has been a game changer in treating kidney disease remotely and its staff have made a huge, positive difference to the lives of dialysis patients in the bush.”
McCarthy said that while organisations such as Purple House are reducing the overall impact that kidney disease has on Aboriginal communities, there is still work to be done when it comes to improving access to safe water.
“Over 500 First Nations communities do not have regular water quality testing. Drinking water supplies in some First Nations communities in remote areas may have levels of uranium, arsenic,
fluoride and nitrate that exceed allowable levels in the Australian Drinking Water Guidelines,” she said.





Late last year, the Federal Government broadened the remit of the National Water Grid Investment Framework to include funding for essential town water supplies in remote communities, McCarthy said.
“Changes to the framework will allow funding to improve water security for First Nations communities, increasing resilience to climate change and supporting economic opportunities,” she said.
“All Australians should be able to expect access to safely managed drinking water and sanitation services in line with Sustainable Development Goal 6, and our government is committed to make this a reality.”
more
With KAESER rotary, screw and turbo blowers, you can be assured that you are investing in high quality - Made in Germany, energy efficient and Industrie 4.0-ready compressed air technology that delivers more air and more savings. But, it doesn’t stop there. When you choose KAESER to be your compressed air partner you get so much more. From Australia-wide 24/7 service support, analysis and advice to a range of bespoke solutions - our expert team are on-hand to ensure that your compressed air system operates at its optimum, reliably and efficiently throughout its lifetime.

For more air, more savings and so much more, make KAESER Compressors your compressed air partner!


1800 640 611 au.kaeser.com




analysis
advice project solutions
air. more savings. and so much more. Sales 24/7 Service
+
Indigenous patients here are living longer on dialysis than the average non-Indigenous person in a metro city on the east coast.
Community
Sarah Brown AM, CEO, Purple House
CASE STUDY #3
STORYTELLING SCIENCE
PROJECT: Indigenous research methodologies
REGION: Australia-wide
LEADER: Associate Professor Bradley Moggridge
Indigenous storytelling is a time-proven method of retaining scientific observation. Associate Professor Bradley Moggridge is working to bring that knowledge into broader circulation.
By Chris Sheedy
Australia is the driest inhabited continent on Earth and, when it comes to water, has access to one of the world’s oldest knowledge systems.
Tragically, says Bradley Moggridge, Associate Professor in Indigenous Water Science at the University of Canberra, that knowledge system

has absolutely no influence on when and where water flows, how water is managed or who owns it.
“Australia’s Indigenous people have survived sea-level rise, our stories talk about climate, they talk about flooding, they talk about droughts, and about the knowledge of where water is and where it should move in the landscape on the driest continent on Earth, yet we don’t celebrate or value that knowledge,” he said.
Bradley Moggridge on the Finke River.
86 Discover more. awa.asn.au Ozwater’23
“History tells me that Aboriginal people are left well and truly behind with regards to water, including access to knowledge, respect for knowledge, knowledge as an equal to western water management and science, and then, obviously, ownership.
“When water was given away, my mum and my grandparents were not seen as human. So they had no rights to actually own water or land.”
As Australia has recently shifted from a period of severe and crippling drought to a time of floods, Moggridge said it’s of concern that there is now less call than ever for input from water scientists. Instead, authorities are simply interested in flood modelling.

And whether it comes from a water scientist or not, he said, Indigenous knowledge around water has never been taken seriously. This is despite the fact that numerous research studies by non-Indigenous academics have proven the scientific veracity of Indigenous storytelling.
WHAT WE KNOW ABOUT FIRST NATIONS WATER KNOWLEDGE
A paper titled Indigenous Research Methodologies in Water Management: learning from Australia and New Zealand for application on Kamilaroi Country, co-authored by Moggridge, Ross Thompson and Peter Radoll, says there are several examples of such evidence.
“Hamacher and Norris (2016) related known cosmic impacts and meteorite falls to Australian Aboriginal stories,” the paper states. “Scientific investigations have confirmed Traditional Knowledge of Quaternary volcanism by the Gugu Badhun people in Queensland, Australia (Cohen et al. 2017). Landscape features prominent
in Indigenous stories have been identified beneath the sea at multiple locations around Australia, indicating that the stories pre-date the most recent period of post-glacial sea-level rise 7000 years ago (Nunn and Reid 2016).”
This knowledge, handed down via generations through storytelling, can offer powerful advantages, the paper reports.
“In recent times it has been shown that there are profound benefits in incorporating Indigenous Knowledge into natural resource management and through participatory mapping (Robinson et al. 2015). This includes water management, pest management, native and cultural or
threatened species recovery (Leiper et al. 2018) and fire management (Williamson et al. 2020).”
Moggridge submitted his PhD thesis on how Indigenous Traditional Knowledge can influence western water management. Part of his research was about trying to identify places in the Australian landscape that cultural indicators suggest water has been in the past and is not today.
“First, it’s important to understand that there are wet and dry times,” he said. “The physical environment and the water system need dry times.
“But in modern Australia, there are diversions or other infrastructure put in place to move water away from
Community 87 Australian Water Association
Town of Mannum and flooded Murray River.
CASE STUDY #3
certain landscapes. That’s what I’ve identified in my research. It means there are places in wetland landscapes where water is not getting to, but where it should be. And so, when we see big flows, that’s the only time you get water in there.”
WHERE TO FROM HERE?
What is the solution? How does Australia benefit from the wealth of water knowledge held within First Nations wisdom?
Moggridge said it has to begin with a better understanding of, recognition of and respect for Indigenous Water Knowledge in the first place.
“I’d love to have a research centre of excellence to build knowledge concepts that actually influence water management,” he said.
“There are not many Indigenous people in the research space, so we need to work out how we can get them into academia.
“That’s also a part of my PhD. When the Murray-Darling Basin Plan was generated, Indigenous Knowledge wasn’t seen as evidence, and it’s still not. So Indigenous Knowledge is not part of the decision-making.
“If anything, we’re advisory, and our advice is never taken. The Basin Plan gives Indigenous values regard, and that is not a strong word in legal terms. It’s non-committal. It means nothing.”
Of course, there has also been state-based support for initiatives such as the Aboriginal Water Initiative (AWI) in NSW, which was discontinued in 2017.
“The AWI generated a staged process for Indigenous engagement that focused on Indigenous-led engagement on Country, strict formalisation of IP arrangements
and databasing of Indigenous values through a standardised methodology (Moggridge et al. 2019),” Moggridge’s paper states.
“The AWI had three priorities and worked under six principles for culturally appropriate methods for engaging Aboriginal people in water, including well-articulated governance structure (Moggridge and Thompson 2021). The AWI was discontinued in 2017 by the NSW government with a cut in funding and removal of the unit.”
Moggridge also said the Indigenisation of the current
education curricula, from preschool to university, is vital to ensure current generations understand Traditional Knowledge.
A national Indigenous Water Strategy, Indigenous water units in each jurisdiction, including specialists such as river rangers, should also be in place.

This should all lead to a change in water laws, which currently still benefit the landowner, Moggridge said. Current laws value water purely as a commodity with a dollar value.
“It’s not seen as a without-it-youdie resource,” he said. “There is no interaction with water as something that sustains life. In such a dry landscape, water should be seen as more significant.
“Right now, any water that goes to the environment is considered wasted water. The Basin Plan is trying to recover water for the environment, but we’re still at a point where way too much water is being extracted.
“If you look after water, water will be healthy, Country will be healthy, people will be healthy.”
I’d love to have a research centre of excellence to build knowledge concepts that actually influence water management.
“
88 Discover
Ozwater’23
The winding Murray River.
more. awa.asn.au
INTEGRATED WATER ENGINEERING SOLUTIONS
Providing complete turnkey solutions by combining an understanding of your requirements with our problem-solving expertise and water and wastewater infrastructure capabilities.
A specialist business unit within SA Water, our capabilities span the entire asset lifecycle from specification to design, construction, maintenance and refurbishment of water and wastewater treatment plants, pump stations, and distribution systems.
We deliver projects for local government and industry across South Australia through our six fully equipped engineering workshops. Call us on 1300 806 855 or visit us at stand P14 at Ozwater’22 to learn how we tailor a solution for you. waterengineeringtechnologies.com.au

ACTIVATED CARBON AND OZONE SPECIALISTS















• Ozone and Activated Carbon Application Studies including batch, jar and column tests for assessing organics and algal metabolite reduction








• Pilot Plant Hire, Operation and Analysis
• Experimental Design
• Biological Activated Carbon (BAC) Aging Profiles



• Biodegradable Dissolved Organic Carbon (BDOC) Testing


• Assimilable Organic Carbon (AOC)
• H2S Breakthrough Capacity







• Full scale plant audit and optimisation studies


RESEARCH LABORATORY SERVICES PTY LTD
Box 50, Eltham, Victoria, AUSTRALIA
+61 3 9431 2595
PO
Phone:
Email: peta@researchlab.com.au www.researchlab.com.au
To discover more innovation news, visit awa.asn.au/news




92 DIGITAL GREENING
Water businesses are boosting investment in digital to achieve e ciencies and emissions reductions, with digitisation emerging as a key lever in meeting sustainability goals.







Technology, development and digitisation
98 WATER RECLAMATION WONDER A look inside Singapore’s digital-first
GREEN HYDROGEN MARKETS Details on the success of
Tuas Water Reclamation Plant. 102
the Hydrogen Energy Supply Chain project.
91
DIGITAL GREENING



















92 Discover more. awa.asn.au Ozwater'23
By Martin Kovacs
Sustainability has long been an overriding focus for the Australian water community, which is entrusted with developing forwardlooking strategies that address ongoing water scarcity issues. As climate change both exacerbates many of the concerns the sector has historically faced and creates a raft of new challenges, digital technologies have an increasingly important role to play in helping to meet sustainability goals.
This comes amid the evolving push towards net-zero emissions, with the sector currently embarking on a range of initiatives as it tackles its wider Scope 1, 2 and 3 emissions profile. Across the sector, notable initial progress has been made in mitigating Scope 2 emissions via the deployment of renewable energy technologies.
Meanwhile, Scope 1 emissions such as wastewater treatment emissions, and Scope 3 value-chain emissions, present increasingly complex and integrated challenges. In these and other areas, digital technologies can potentially be harnessed to deliver long-term value.
As noted by Matt Lyon, WSP Senior Engineer for Water, the current expansion of the sector’s historical sustainability focus goes hand in hand with its ongoing adoption of digital technologies.
“Environmental sustainability is always something the sector’s had to consider,” Lyon said. “It’s embedded in the way utilities operate, through
licence conditions and socially responsible business practices. Now these goals are being expanded with additional sustainability and net-zero targets, and utilities are exploring how digital solutions can help them meet these challenges in the most cost-effective way.”
ON THE RISE
Schneider Electric’s Sustainability Index 2022, based on a survey of 500 business decision-makers, notes digital technology was widely identified by respondents as “playing a key role in achieving sustainability goals”, with Australian companies ramping up investment in this area.
According to the index, business leaders are looking to the longterm benefits of further integrating sustainable practices at both a business level and across value chains as part of the ongoing digital transformation process.
Lyon said there is a growing recognition of the role digital technologies can play in achieving sustainability goals as net-zero targets draw closer.
“Over the last 18 months there’s been rapid changes in the sector,

with more utilities setting net-zero targets,” he said. “We’re also seeing utilities adopting more stringent targets on nutrient discharges to waterways out of wastewater treatment plants.
“In terms of Scope 1 emissions, more utilities are now measuring fugitive nitrous oxide and methane emissions. Going forward, we could see utilities integrating emissions monitoring with digital models for real-time emissions tracking and scenario testing.”
Duncan Whiteley, WSP Data Science and Analytics Operations Lead, said some utilities are also beginning to consider sustainability and carbon output as part of their procurement processes.
“Looking ahead, we could definitely see a directive for consultants to quantify carbon in every project put forward, including Scope 3 emissions,” he said.
To this end, he advised that WSP Australia “has taken a leadership position by committing to halving the carbon footprint of its designs and advice by 2023”.
As mandatory sustainability and emissions assessments continue to become the norm, Whiteley noted there is a “huge opportunity in this space as digital twins begin to be implemented on more projects”, providing the potential to harness project data to quantify carbon impact over the lifecycle of an asset.
“Early digital twins focused on how can we get the design built or the asset maintained in a way
Water businesses are boosting investment in digital to achieve efficiencies and emissions reductions, with digitisation emerging as a key lever in meeting sustainability targets.
Going forward, we could see utilities integrating monitoring with digital models for real-time emissions tracking and scenario testing.
Innovation 93 Australian Water Association
Matt Lyon, Senior Engineer for Water, WSP
that reduces cost and reduces variation in the design during construction,” he said.

“However, we are now integrating other data into these models to quantify other parameters, such as carbon emissions. With this rich dataset, you can then simulate infinite scenarios and optimise your design to meet your project’s objectives.”
FLEXIBILITY AND INNOVATION
SpiralData CEO Kale Needham said the broader water community is becoming increasingly proactive in both tying sustainability goals to existing practices and in undertaking new initiatives to achieve these goals.
With the core of utilities now starting out on the path to digital transformation, Needham noted the next three to five years “will be very exciting in the water space”.
“With the nature of water being precious and scarce, it aligns closely to sustainability goals,”


he said. “And it also lends itself to smart technologies to help achieve these goals.

“Once we start talking about cutting waste and efficiency, this really gets into the problem space of digital transformation at a higher level, which from our perspective is where data science and big data comes in.”
In effectively harnessing data insights, utilities will need to both prioritise flexibility and have scalable processes in place that encourage innovation, Needham said.


There are a lot of traps to practically achieve better decisions through data, Needham said, and it’s important to initially identify underlying problems, rather than focusing on the solutions first.
Utilities can set about leveraging data to optimise different areas of operations, with Needham describing a scalable data lake, allowing for data storage, processing and linking, as an enabler to solve problems.
“Having an innovation process in place, with the ability to extract and push data in a range of different directions, is really important,” he said. “In keeping the scope narrow to start with, you can then build out a data lake as you solve the problem.
“You’re ingesting data for each problem as required, and then expanding it as you solve each subsequent problem. That way, as the data matures and continues to grow, it’s based around your problem space.”
BROADENING THE SCOPE
Underscoring the potential to progressively broaden the scope of data-driven processes, a project undertaken by WSP in conjunction with Hunter Water, harnessing machine learning to bolster Hunter’s leak detection program has evolved over time to deliver additional benefits.
Whiteley said the project – which had initially explored methodology to improve the rate of leaks found per kilometre
Murrumbidgee Irrigation control room
Having an innovation process in place, with the ability to extract and push data in a range of different directions, is really important.
Kale Needham, Chief Executive O cer, SpiralData
94 Ozwater'23 Discover more.
awa.asn.au




















16 - 22 October 2023 UNITED BY WATER nationalwaterweek.org
surveyed using WSP’s machine learning model to prioritise surveys – has since expanded to consider the full asset lifecycle.
“Rather than just focusing on predicting where network leaks would occur, we looked at leaks and breaks as a whole, building a model that predicted how many failures are likely to occur and where they’re going to occur,” he said.



“This model, combined with a digital twin, provides insights into the cost of maintaining those assets long term versus the cost of renewing those assets.”
Whiteley said this automated cost-benefit analysis allows Hunter Water to not only choose the most cost-effective option, but also promotes greater efficiency and reduces resources consumption.
“They’re reducing their carbon footprint by default,” he said. “By automating this analysis for the entire network, the renewal with the highest cost-benefit is prioritised, overall reducing the number of times they’ve had to go to that site and repair a failure.”
Further, Whiteley pointed to the potential to configure this type of modelling based on carbon impact.
“That’s where it’s key to integrate datasets into a centralised data lake,” he said. “Currently the system uses geospatial data and records of maintenance jobs to predict future failures.

“With access to other data sources such as SCADA, we can improve the model further by providing an overall bigger picture of the network’s performance and real-time data on the rate of rise within the network.”
SUSTAINABLE IRRIGATION


Murrumbidgee Irrigation (MI) General Manager of Information Systems Andrew Pasquetti said MI’s automation of its delivery network has been a major catalyst in achieving water savings and enabling a sustainable future for irrigation communities.

Pasquetti said this automation allows for real-time network monitoring and management, paving the way for the timely delivery of water.

“Our customer operations centre leverages the automated system’s centralised visibility, allowing operators to monitor and control MI’s infrastructure and respond rapidly to any failures,” he said.
MI is additionally utilising CCTV monitoring, business intelligence dashboards, high-resolution weather stations and field mobility software, with Pasquetti emphasising the key role of data science toolkits in achieving sustainability goals.

“Our digital twin capabilities inform asset maintenance, and will soon be expanded with the use of 3D spatial platforms,” he said. “This will enable us to use 3D excavation technology to tailor our approach to channel cleaning activities such as desilting and de-weeding.
“We’re aiming to reduce overexcavation risks, provide more streamlined channel maintenance, and reduce heavy wear and tear. This means maintenance life will be greatly extended, and enables optimised network operation.”



Pasquetti noted that being able to effectively harness data insights has required an evolution in MI’s decision-making processes, which have shifted towards “probabilistic methods with the key downside risks appropriately managed”.
Once an issue has been identified, a range of tools are then used for data collection, cleaning, visualisation and analysis in determining how to improve system performance.
“The value an organisation can glean from data is not linear,” he said. “New datasets that are contextualised with existing datasets can unlock benefits to help solve business problems.
“MI is continuing to integrate technology, people and processes, while being open to new datasets that can unlock value for our customers through digital transformation.”
Murrumbidgee irrigation
New datasets that are contextualised with existing datasets can unlock large benefits to help solve challenging business problems.
96 Discover
Ozwater'23
Andrew Pasquetti, General Manager of Information Systems, Murrumbidgee Irrigation
more. awa.asn.au
GRADIANT
CORPORATION
Bringing global technologies to Australian customers


The Gradiant technology portfolio includes:

ROinfinity™ (Roi™) achieves minimal liquid discharge at a fraction of the cost and energy through our novel RO and Counter-Flow Reverse Osmosis (CFRO™) processes with advanced automation
Carrier Gas Extraction (CGE™) goes beyond traditional evaporators to meet zero liquid discharge through a patented HDH system


Free Radical Oxidation (FRO™) process removes the most difficult to treat metals/ organics at lower costs than conventional advanced oxidation processes
SmartOPs™ merges people and technology to provide innovative asset performance management service to optimise water and wastewater assets over their lifecycle via real time, data driven AI/ML platforms reducing overall asset ownership cost

WE KNOW WATER
CONTACT US TODAY www.watertreatment.net.au Building 4, 9 Packard Avenue, Castle Hill NSW 2154 P +61 2 9899 7811 E info@watertreatment.net.au
CASE STUDY #4
HIGH-SCALE TRANSPARENCY
PROJECT: Tuas Water Reclamation Plant

REGION: Singapore
STARTED: 2017
LEADER: PUB, Singapore’s National Water Agency
An award-winning, digital-first approach for Singapore’s Tuas Water Reclamation Plant has revealed the astounding power of data-driven water engineering.
By Chris Sheedy
When construction is completed in 2026, Tuas Water Reclamation Plant (TWRP), on 54 hectares of reclaimed land on Singapore’s west coast, will be the largest membrane bioreactor in the world. It will be the destination
for up to 800,000 cubic metres of used domestic and industrial water a day. That’s a capacity equal to 320 Olympic-sized swimming pools. The used water will have travelled by gravity along a new sewer superhighway consisting of 40km of underground tunnels and 60km of underground link sewers. Collectively, they make up Phase 2 of Singapore’s Deep Tunnel Sewerage System (DTSS).
Design ideation for the Tuas Water Reclamation Plant.
Images supplied by PUB Singapore 98 Discover more. awa.asn.au Ozwater'23
When the treated, high-grade water – branded NEWater by Public Utilities Board (PUB), Singapore’s national water agency – comes out the other side of TWRP, it will be fit for use in industrial settings, reducing pressure on the island nation’s potable water supply.
Singapore has long faced challenges in maintaining a sustainable supply of potable water. With limited fresh water resources and an increasing population, the country is heavily dependent on imported water. Advanced treatment technologies such as desalination and water reclamation have become essential tools in the development of a longterm water solution.
“TWRP important to us because water is a precious resource that we can’t afford to waste. With Singapore’s land constraints, the amount of rainwater we can collect is limited. We had to diversify our sources,” said Tiong Sen Go, Senior Engineer at PUB.
The Singapore Government has implemented various public education programs to promote water conservation, including the use of water-efficient appliances and raising awareness of water scarcity.
16 CONTRACT PACKAGES
On the infrastructure side of the solution, TWRP looms large.
Jacobs, the detailed design and construction supervision consultant on the project, has overseen 16 tier-1 contract packages that must be completed before the plant can come online. Eleven contracts have currently been awarded.
“This project is so big, the scale is enormous,” said OhSung Kwan, TWRP BIM Manager with Jacobs. “The challenge was always around how we are going to combine these various parts, considering the project’s scale.”

The solution was to democratise project information from the very

beginning, from prior to sending out the various contract packages for tender.
“Instead of the traditional drawings in tender briefs, we issue a highdefinition, 3D-design visualisation model out for tender for the projects,” Kwan said.
“Because of the complexity of the project, a 3D model better conveys what is expected and required. It helps speed up the time for contractors to appreciate this project and to come up with a competitive price. It has now become a benchmark for other projects to follow.”
In fact, with the aid of digital delivery via Bentley Systems’ cloudbased engineering software, and NVIDIA for model visualisation, the TWRP program has reduced traditional timelines for the multidisciplinary design tendering process by 50%. The use of a single digital platform, and the added value it brings to the engineering process, has
also cut forecast capital expenditure by 5%. Some of this saving comes from the fact that over 1000 drawings no longer have to be produced, freeing up a large amount of time and resources and contributing to a 75% reduction in model federation time.
The digital model is not just used for the tendering process. Its photogrammetry capabilities mean stakeholders can follow construction progress in real time. Its 4D sequencing dramatically improves logistics processes. The digital twin model allows walkthroughs to ensure detailed design changes don’t have unintended consequences.
Customised, intelligent data produced during construction will also benefit operations and maintenance teams for decades.
Kwan said it takes just a few minutes of effort to ensure individuals from every business connected to the project can access the digital twin models, which enables walk-throughs, fly-overs and deep dives into details.
“You don’t even need to download or install any specific software,” he said. “You just open a browser on your desktop, laptop or tablet, then start from there. Of course, if you’re one of the modellers, you need specialist knowledge. But to work within the model and see everything you need to see to do the job, it takes a few minutes to learn.”
COMBINING PROCESSES
TWRP has a smaller than usual footprint not just because it has been restricted to a relatively small plot of land by building upwards, but also because its membrane bioreactor replaces several processes.
A membrane bioreactor (MBR) facility for water treatment combines biological wastewater treatment processes with membrane filtration. Microorganisms break down organic matter in the biological
This project is so big, the scale is enormous. The challenge was always around how are we going to combine these various parts, considering the project’s scale.
Innovation 99 Australian Water Association
OhSung Kwan, TWRP BIM Manager, Jacobs
CASE STUDY #4
part of the process, before membrane filtration removes any remaining suspended solids and microorganisms.
The MBR process replaces more traditional treatment steps including the conventional bioreactor process and secondary sedimentation, micro-filtration and ultra-filtration stages. The entire process is streamlined, as is the infrastructure required to treat and reclaim wastewater at such scale. It produces higher-quality effluent, which is further purified.
MBRs are not uncommon in the treatment of municipal and industrial wastewater, but on this scale, they simply don’t exist anywhere in the world.
“Phase One of the DTSS was completed in 2008,” Go said.
“That sent wastewater to the east, to Changi. With Phase Two, we have a similar network of tunnels conveying wastewater to the western part of Singapore.

“When it’s complete, there will be a full network of tunnels to convey wastewater to the eastern and western sides of Singapore for treatment.
“The new plant will significantly enhance our used water treatment capabilities and have a positive effect on Singapore’s water sustainability goals.”

PLANT
The new plant will have a significant and positive effect on Singapore’s water sustainability goals.
Tiong Sen Go, Senior Engineer, Singapore PUB
Largest membrane bioreactor facility in the world Highquality e uent production Plant is built upward for natural ventilation and lighting Up to 85% recovery from domestic used water Roof space used to produce solar energy Closing the water loop by recycling Smart plant requiring less manpower to operate and maintain More than double energy recovered from used water Leverage on the waterenergy-waste nexus Source: Singapore PUB 100 Discover more. awa.asn.au Ozwater'23
Marina Barrage and Marina Channel in Singapore.
FEATURES OF TUAS WATER RECLAMATION
A NEW CONCEPT FOR WASTEWATER LAGOONS
Lagoon Aerator

Innovative sludge aeration technology that cleans water and wastewater in ponds, lakes and lagoons, while lowering energy costs by up to 80%.
FEATURES
Only 3 kW at maximum energy used
Moves 37,000m3 of water every day
No propellers or shafts to foul
No belts or gearboxes to break or require maintenance
No metal frame, so no corrosion
Made from recycled HDPE
The addition of up to 3.0 kg/O2 per hour
4 x Kuh Kai Aerators move and mix water through the Lagoon Aerator
BENEFITS
Continuously moves the lagoon or pond water via vertical mixing, for complete destratification, algae bloom reduction, and natural sludge digestion

Delivers more dissolved oxygen to the water per hour





Lowers energy costs by up to 80%
Practically maintenance free for years
Eliminates trapped nitrogen and ammonia gases, and improves BOD/COD counts
Optimise your site to reduce energy consumption and improve your water quality
ROYCE WATER TECHNOLOGIES PTY LTD ABN 21 110 057 399 www.roycewater.com.au QLD / NT / PNG & NZ PHONE 0437 742 859 NSW / TAS & ACT PHONE 0429 623 308 VIC & SA PHONE 0439 337 247 WA PHONE 08 9467 7645
CASE STUDY #5
THE POWER BEHIND WATER
PROJECT: Hydrogen Energy Supply Chain Project

REGION: LaTrobe Valley, Victoria
STARTED: 2018
A new project is transforming increasingly unviable brown coal into a lower-emission fuel to help decarbonise the energy, transport and industrial sectors.
By Cole Latimer
The world is undergoing an energy transition, moving away from fossil fuels like coal to cleaner energy sources as nations turn to long-term solutions to climate change. Lower-emission fuels and renewable energy like wind, solar and hydro-power are becoming more common across the world.
One other fuel gaining traction is hydrogen, or H₂. Australia is taking a lead in developing hydrogen that can be shipped in large scale anywhere in the world, creating a potential new energy export industry.
Through the Hydrogen Energy Supply Chain (HESC) project, Australia is learning how to transform high-emissions brown coal into cleaner hydrogen, and, by combining it with carbon capture and storage
Liquid hydrogen receiving terminal in Kobe, Japan.
Images
102 Discover more. awa.asn.au Ozwater'23
supplied by HySTRA
technology, turn it into a net-zero fuel. The CSIRO has played a role in helping to advance the pathway for hydrogen in Australia, and contributed to the research and development of the HESC project.
“The HESC project is a globally significant first-of-a-kind demonstration of the potential to produce and move clean energy between countries in the form of hydrogen,” CSIRO Hydrogen Industry Mission leader Dr Patrick Hartley said.
The project is also creating a potential new clean energy export industry for Australia, putting it at the forefront of supply for an expanding Asia-Pacific hungry for lower-emissions fuels.
“Australia, with its abundant renewable and fossil fuel/carbon capture and storage resources and relatively small domestic energy demand is in an excellent position to contribute to the development of a global clean energy export/import market,” Hartley said.

And as hydrogen processing requires water, it has potentially created a new market for utilities to use non-potable water to help power the nation and the world.
WHY HYDROGEN?
Hydrogen is potentially a zero or net-zero, emissions fuel, that produces only water vapour when burnt. The world’s most abundant element, hydrogen is a lowemissions fuel that could potentially decarbonise high-emitting sectors, like power generation, heavy industry, manufacturing, and commercial and private transport.
“Hydrogen technology is an increasingly viable option – both from an economic and technological perspective – for displacing fossil fuels in a range of applications, particularly those in which electrification is either
difficult or not preferred by the consumer,” Hartley said.
It can be produced in a variety of ways. ‘Renewable’ hydrogen is produced from water using electrolysis, where electricity is generated from renewable sources for electrochemical water splitting; and ‘clean’, often called ‘blue’ hydrogen, is produced from fossil fuels via thermochemical processes, which uses both water and the fuel as sources of hydrogen, before capturing and storing the CO2 generated to make it a net-zero emissions fuel.
The International Energy Agency expects demand for hydrogen to increase by around 44% to 2040, reaching around 180 million tonnes in 2030 alone, particularly in the heavy industry and power generation spaces. The need for more hydrogen is growing.
THE HESC PROJECT
Launched in 2018 with its its pilot phase completed in 2022, the $500 million HESC project is based in Hastings, in Victoria’s Latrobe Valley. It aimed to demonstrate a holistic, endto-end integrated hydrogen supply chain that runs from initial production and storage of hydrogen through to transportation and eventual delivery of liquified hydrogen to Japanese heavy industrial companies.

This was a major development as hydrogen had never been shipped in liquid form on this scale before.
“The project demonstrated for the first time that a liquid hydrogen supply chain between Australia and Japan is feasible from the technological perspective, and in particular involved the development and demonstration of first-of-a-kind hydrogen transport infrastructure
The project demonstrated for the first time that a liquid hydrogen supply chain between Australia and Japan is feasible from the technological perspective
Dr Patrick Hartley,
Hydrogen Industry Mission Leader, CSIRO
Innovation 103 Australian Water Association
Liquefaction loading facilty at the Port of Hastings in Victoria.
CASE STUDY #5
both in Australia and Japan,” Hartley said.






While the costs of the demonstration project were presumably high, given its first-of-a-kind nature, he said “the learnings from the many technological components that were demonstrated would be useful to new market entrants”.
The project works by turning brown coal – which is 60% water – into a gas by partially burning it to generate carbon dioxide. This CO2 reacts with the remaining carbon in the coal to make carbon monoxide. This carbon monoxide gas is reacted with steam to make hydrogen gas and CO2 again. The hydrogen is then super-cooled into a liquid, which can be transported.
By producing hydrogen from coal at a large facility in situ, it also allows for tighter emissions controls to be put in place as the coal is processed, reducing the potential for Scope 3 emissions that would have been created if the coal was used for power generation.
It will capture carbon dioxide released during the production phase and store it through the CarbonNet project, which is studying the establishment of a commercial-scale carbon capture and storage (CCS) project about eight kilometres off the Gippsland coast, about 1.5 kilometres beneath the seabed. This project is slated to be operational by 2027.
The project aims to scale up to a commercial phase in the 2030s, targeting a potential liquid hydrogen production of about 225,000 tonnes a year, depending on the success of the pilot phase, as well as regulatory approvals, hydrogen demand and the support of effective CCS
technologies that can help reduce the project’s emissions.



This has put Australia on the front foot to become a global hydrogen exporter, laying pathways for future infrastructure and markets.

WATER OPPORTUNITIES
The impact that a shift towards hydrogen production will have on water will be in its increased demand for fuel creation.
“Water is a critical source of hydrogen for all hydrogen production methods,” Hartley said.


However, the generation of these forms of hydrogen don’t necessarily





require potable water. This demand for water opens up a potential market for water and sewage utilities to also become power producers themselves, as the HESC has demonstrated that using nonpotable water sources works and there is a market, and transport, for Australian-made hydrogen.

By using effluent or even separating hydrogen from synthesis gases generated through processing sludge, wastewater utilities could follow the example of the HESC project by becoming power producers, while also reducing their own emissions.

Transport Electricity systems Industrial processes Export Gas networks Services RD&D Manufacturing HYDROGEN OPPORTUNITIES 104 Discover more. awa.asn.au Ozwater'23
Untap the sustainability potential of digitising your network.




Our customers work in remote, difficult to reach, harsh environments, and face a myriad of power and connectivity challenges - at the far edge - that’s where we live.











Gain real-time visbility of your water and wastewater networks with the NEW Captis Version 1.2. Your complete IoT monitoring and measurement solution - device, cloud, connectivity.


1800 646 828 | miot.com.au
™
Water sector owners and managers of critical GRP/ FRP assets can now call on RPC’s almost 50-years of experience to assist them in their asset management programs. RPC’s successful record of designing, engineering, manufacturing and installing major FRP assets for Governments and asset owners is unmatched in Australian and South East Asian markets and we now bring that unique knowledge to the Asset Management and Services sector. Quality asset management ensures:

• Better informed value decisions
• Enhanced performance and asset life
– Improved ROI
• Superior risk management
• Safety and efficiency of supply to the communities they serve
Working in partnership with Asset Managers, RPC can test and inspect one asset, such as a tank or pipeline, or provide a strategic program of GRP/ FRP testing and reporting for an entire facility.

In addition to our experience, RPC utilises the world-first UTComp UltraAnlaytix™
In-Service Testing system that enables condition assessments of assets while they are still operating eliminating the need for costly shutdowns or confined-space inspections. Join our valued customers already utilising our Asset Services capability including Sydney Water, BHP and Veolia.

Visit us at OzWater on stand Q16 to find out more or call Glen Jameson, Manager - Asset Services on +61 439 046 617 or glen.jameson@rpctechnologies.com www.rpctechnologies.com RPC – Your trusted partner in GRP/FRP Asset Management Services.
action at
OPTIMISE YOUR GRP/FRP ASSET PERFORMANCE Introducing RPC Asset Services
UltraAnalytix™ testing in
Penrith WWTP
Malabar WWTP, NSW
1278 RPC Current OzWater 21 Full Page Ad.indd 1 31/3/2022 1:49 pm
Googong WWTP, NSW
130





STUDENT EDITION
The Australian Water Association’s inaugural Water e-Journal Student Edition was launched in 2022, featuring an array of outstanding technical papers produced by students across Australia.
To discover more technical papers, visit awa.asn.au/resources/water-e-journal






The latest technologies and insights for water professionals 108 OPTIMISATION MODELLING Understanding the potential groundwater shortfall in north-east Perth. 121 REMOVING POLLUTANTS Biofiltration’s e ect on removing pollutants in stormwater. 123 BUSHFIRE CONTAMINANTS Identifying treatment options for bushfire-related contaminants.
GUIDANCE VALUES Ensuring chlorine discharges don’t adversely impact marine environments.
DEMAND PATTERNS
patterns
water system hydraulic models.
DIGITAL TWIN TECHNOLOGY
safety outcomes and asset inspections
twin technology. 111 CIRCULAR OPTIONS Evaluating circular economy options in Yarra Valley Water’s 2030 Strategy. 115 CHLORAMINE TRIALS How a chloramine dosing trial helped improve public health benefits. 112 SYSTEM SERVICES Providing strategic change towards water sensitive city visions. 118 SECONDARY CLARIFIERS Identifying and addressing limitations through full-scale testing.
125
129
Optimising demand
in
116
Optimising
using digital
107



























108 Ozwater'23 Discover more. awa.asn.au Aerial view of downtown Perth.
“
Applying this model to a range of urban design and planning scenarios, we were able to identify critical factors influencing the potential water supply-demand gap.
Optimisation modelling for potential groundwater shortfall
Western Australia’s Perth and Peel regions are growing rapidly, with a population of over 2 million in 2016 projected to grow to 3.5 million people by 2050. Traditionally, the green spaces in urban areas have been irrigated with groundwater. This has allowed a high standard of green space amenity at low cost, despite Perth’s dry summers.
However, as Perth grows, urban development is increasingly moving into areas with limited groundwater availability for the irrigation of green spaces, as well as areas that are seasonally inundated due to shallow (but limited) groundwater.

There is a need for high-quality green spaces as a component of urban liveability, for the physical and mental health and wellbeing of communities, and for the potential to combat rising temperatures in urban areas
(WA Government 2019, Productivity Commission 2020). Water availability is key in providing these green spaces. This paper presents a case study in the north-east of Perth, where optimisation modelling was applied to understand the potential groundwater shortfall in an area undergoing urbanisation. The optimisation objective was to minimise the total gap between water supply and demand across all sub-areas (units of groundwater management) through a different selection of groundwater sources within the sub-areas, and aquifers available to each development. Applying this model to a range of urban design and planning scenarios, we were able to identify critical factors influencing the potential water supply-demand gap. From this, strategies were developed to guide planning and reduce the likelihood that additional water sources will be required. We believe this is the first time an optimisation modelling approach has been applied to groundwater planning in WA. Current business-as-usual is for trades and transfer of groundwater licences (movement of a water licence from one party to another, taken from a different location or the same location, respectively) to progress on an ad-hoc basis, without detailed scenario planning. The key benefit of this approach is that it allows local government to examine the relationship between urban liveability, planning decisions, local planning and design policy, and other factors that will trigger the need for additional water sources.
109 Australian Water Association Technical Papers
Optimisation modelling was applied to understand the potential groundwater shortfall in Perth’s urbanising north-east.
TO READ THE FULL ARTICLE visit the Water e-Journal at bit.ly/water_e_journal or scan the QR code
Melissa Bromly, Maedeh Shahabi and Matthew Awang





THANK YOU FOR THE SUPPORT OF OUR PRINCIPAL AND PLATINUM MEMBERS https://www.awa.asn.au/membership/corporate Upgrade your corporate membership at: OUR PRINCIPAL MEMBERS OUR PLATINUM MEMBERS
Evaluating and comparing circular economy options in Yarra Valley Water’s 2030 Strategy

The circular economy is a framework that aligns economic and environmental interests by retaining maximum value in products, components and materials. This is achieved by establishing systems in which assets and products are: designed to last longer; be shared, repaired, repurposed and remanufactured; and only after several ‘lives’, be recycled to recover materials.
Yarra Valley Water (YVW) recognised that to meet its 2030 strategic objective to deliver a healthy ecosystem, it needed to adopt a ‘regenerative’ mindset –recognising that meeting compliance is not enough to prevent environmental degradation. The regenerative approach means looking more holistically at impacts and opportunities. YVW identified that to enact this change it needed to focus on three areas: ‘Beyond Zero Carbon’, ‘Healthy Ecosystems’ and ‘Circular Economy’. This commitment was developed together with the board and is integral to how the
utility undertakes its core business, rather than an add-on. This paper describes the development and application of a circular economy analysis framework, created especially for water utilities, to inform strategy development and implementation. The work was triggered by YVW recognising the need to build circular economy principles into its 2030 strategy.
Drawing upon international best-practice in circular economy and sustainability assessment, the framework was used to conduct a pilot circular baseline analysis of the business. The flows of water, nutrients and materials into and out of the business were mapped and evaluated, and the level of circularity of each flow was calculated using the material circularity indicator.
Lifecycle assessment was used to translate these materials’ flows into impact on climate change. This combined approach allowed the comparison of a suite of circular economy options that were generated through a cross-business engagement process. The circular economy analysis framework revealed the most meaningful and impactful opportunities among the options, also highlighting tradeoffs between different project types.
New opportunities to embrace the circular economy were identified that go beyond the water cycle in terms of both impacts and benefits, such as in construction materials and methods. Thorough analysis, alongside strong staff and contract partner engagement, created new ideas and momentum for the circular economy.
Technical Papers 111 Australian Water Association
This innovative project resulted in the development of a circular baseline analysis framework specially adapted for water utilities, and identified new opportunities that go far beyond the water cycle impacts and benefits.
Lisa Ehrenfried, Jodie Bricout, Tim Grant and Francis Pamminger
TO READ THE FULL ARTICLE visit the Water e-Journal at bit.ly/water_e_journal or scan the QR code
Helping Australian cities transition to more sustainable water system services
Australia’s water sector is transforming, with profound implications for the health and wellbeing of people and the environment. Governments and water sector organisations are adopting policies and agendas to improve urban liveability with regard to greening, cooling, improved amenity, equity, affordability and safety. But achieving these goals in practice is challenging.
This paper reflects on how the water sector can continue its transformation to meet the challenges of our growing cities and navigate pathways towards greater community value from water system services.
Our insights come from action research with six Australian cities that were guided through envisioning and transition planning processes, utilising the Water Sensitive Cities Index and transition tools
developed by the Cooperative Research Centre for Water Sensitive Cities.
We found that achieving cities’ future water aspirations will only be possible with substantial changes in governance settings that move away from the cost efficiency focus of the 1990s towards broader water-sensitive outcomes. A narrow investment focus on technologies and demonstration projects is unlikely to drive the system changes and momentum needed to support transformation.
While there is still significant work to be done across Australia to achieve water-sensitive cities, there are many opportunities to be leveraged to continue water-sensitive transitions.
Institutional innovations that change the water sector’s operating model are needed, with a focus on the sector's city-shaping role and enabler of urban liveability and resilience.
112 Technical Papers Ozwater'23 Discover more. awa.asn.au
Six Australian cities were examined to provide stakeholders with the insights and guidance needed to provide strategic change towards their water sensitive city vision.
TO READ THE FULL ARTICLE visit the Water e-Journal at bit.ly/water_e_journal or scan the QR code Water Supply City Sewered City Drained City Waterway City Water Cycle City Water Sensitive City CUMULATIVE SOCIOPOLITICAL DRIVERS Urban water transitions framework Water supply access and security Public health protection Flood protection Social amenity, environmental protection Limits on natural resources Intergenerational equity, resilience to climate change
Professor Briony Rogers, Professor Chris Chesterfield and Katie Hammer
YOURPARTNERINBUILDING CIVILWATERINFRASTRUCTURES
CCBEnvicoisagroupofspecialistinfrastructurecontractorswith over20years'experiencethroughoutAustraliaandAsiaPacific.

CCBEnvicohasbeenproudlydelivering environmentalinfrastructureacrossAustraliaand thePacificforover20years.
Workingtogethertodeliverourclients'vision,we havedeliveredover130majorprojectsinvolving thetreatmentofpotablewaterandwastewaterin Australiaandinsomeofthemostremotepartsof theworld.
WithfullDesign&ConstructaswellasContract expertise,ourrecentandcurrentprojects include:
DrouinWastewaterTreatmentPlant(pictured)
BatemansBaySewageTreatmentPlant

EchucaWaterTreatmentPlantUpgrade BulkWaterTransmissionMainandWater SupplyImprovementintheSolomonIslands
CCBEnvicohaspastexperienceinandcurrent capabilitieswiththedesign,construction,and commissioningof:
WaterandSewerageTreatmentPlants
PumpingStations
WaterRetainingStructures
InletWorksandScreening
SludgeHandling
PipelinesandAssociatedCivilInfrastructure CoastalProtectionandSandPumpingStations
Welookforwardtoworkingwithyou.
Contactustoday: tenders@ccbenvico.com
+61(0)393204800
Visitourwebsite www.reevesenvico.com
Efficient Mobile Screening


D:MAX Mobile Screening

Dredging Solutions’ D:MAX mobile screening and classification system enables flexible and efficient processing of liquid waste streams from a range of industries. When utilised during a wastewater digestor cleanout, the D:MAX allows us to generate washed screenings, a dewatered grit output (generally 65% - 70% dry), and a screened sludge stream for further dewatering.

Rotary Drum Screens
Dredging Solutions’ 5mm aperture rotary drum screens allow us to screen at high flows, up to 6000m³/hr with screenings automatically conveyed into an adjacent waste bin. This portable piece of equipment is perfectly suited to the temporary bypass of inlet works or use during digestor and tank cleans.



Sydney Office 02 9634 1712 Townsend Office 02 6645 1180 Perth Office 08 9204 7510 www.dredgingsolutions.com.au
Using chloramine trials to determine the impacts of water disinfection
Cameron Veal, Charlene Wong, Paul Sherman, Phil Wetherell, Jennifer Wain and Duncan Middleton
In the summer of 2016-2017, seven positive E. coli detections were recorded in Urban Utilities' and Logan City Council’s reticulation schemes. While operational and climatic factors may have contributed to ingress and detection, these detections were recorded at times when residual disinfectant concentration did not reach leading practice levels.
Seqwater and water service providers (WSP) agreed to work collaboratively towards optimising current operational infrastructure to increase the effectiveness of disinfectant residual through the bulk and WSP networks. An assessment of the different operational and capital investment strategies found the best net present value of cost and capital cost solution was to increase chloramine stability by an estimated 70% through water treatment plant upgrades.
As this capital investment approach would take several years to adequately
plan, develop and deliver, the increased chloramine dosing program was designed to investigate if a temporary period of increased chloramine dosing could be applied during periods of elevated network chloramine decay.
Over 14 weeks in the Queensland summer (2019-2020), the chloraminated network received an elevated total chlorine residual (4.0 mg/L) as part of a trial to determine if this increase residual had any impact on improved disinfection residuals and reduced microbial detections in the bulk and WSP reticulated networks.

Increased chloramine dosing was observed to improve the total chlorine residual in most of Seqwater’s bulk water network. However, it did not improve the secondary disinfection performance in areas known to have high water age due to network configuration. Observed and modelled information from the trial demonstrated that some water quality indicators slightly improved, compared to the 2018-2019 summer.
The primary objective of the trial was to increase the area of the network that held total chlorine residual >0.5 mg/L. The trial achieved this improvement for three reticulated zones in the Urban Utilities network, all of which were adjacent to Seqwater’s bulk water supply points. Network mode of operation was also critical. The increased chloramine dosing program resulted in an increased number of South East Queensland water customers receiving improved secondary disinfection residuals and associated public health benefits at their meter.
Technical Papers 115 Australian Water Association
How a chloramine dosing trial program resulted in Queensland water customers receiving improved disinfection residuals and associated public health benefits at their meter.
TO READ THE FULL ARTICLE visit the Water e-Journal at bit.ly/water_e_journal or scan the QR code
Using digital twin technology to improve inspection methods of high-risk assets



Digital twin (DT) technology has changed the way critical in-service assets such as elevated potable water tanks are inspected and their condition assessed. With the advent of remote inspection practices, only minimal operational intervention is required to assess the asset deterioration. This facilitates timely asset inspections that can be achieved with a high degree of accuracy in the operational asset management process.
Water Corporation collects vast amounts of data across a range of asset types each year. Harnessing large amounts of data and using technology to visualise and interact with assets has become a key focus. The development of DT technology allows organisations to deal with their historical data, but, more importantly, provides a visualisation platform where complex post-inspection analysis can be made and real-time data can be viewed.
A DT for water assets resides in a cloud-based platform and is created by using the latest advancements in remote inspection technologies, including RGB sensors, laser scanners, LiDAR and drones. The data collection process itself has significant advantages over traditional data collection methods. The time required on site is almost halved and exposure to high-risk activities, such as working at heights and confined space entry, is almost eliminated.
DT technology removes the subjective nature of traditional inspections,




















whereby an inspector often uses basic measurement and data capture tools, and transfers the information captured to a basic paper-based notepad. This type of inspection is subject to human error, and the initial measurements and data captured can't be accurately reviewed or audited. DT technology allows multiple users to not only review inspectors' comments on the condition of the asset, but also gain an exceedingly high-detail, realistic view of the asset itself.
The in-service assets team at Water Corporation has confirmed the use of remote inspection techniques to produce asset DT, improving safety and reduction in inspection cost when compared with conventional inspection approaches. Defects on the assets are located with a higher degree of accuracy, then geo-tagged and labelled, which can be used for timely intervention and renewal decisions.
116 Technical Papers Ozwater'23 Discover more. awa.asn.au
Digital twin technology has increased the safety of personnel, improved data quality and drastically decreased the time and money spent inspecting each asset.
Venkat Coimbatore and Ed Boxall
TO READ THE FULL ARTICLE visit the Water e-Journal at bit.ly/water_e_journal or scan the QR code
Thermal Imagery used to detect leaks and defects.








FROM WATER TO POWER NETWORKS, ALL MANAGED BY A SINGLE SOFTWARE SOLUTION. THAT’S THE POWER OF ONE. TechnologyOne has established a firm foothold in Australasian infrastructure, developing proven software that is applicable to a wide variety of asset-intensive sectors, and is easily accessible from any device. Simple, effective solutions. Exactly why TechnologyOne has experienced 30 years of success and 99% customer retention. TechnologyOneCorp.com AWA11_98-100_TPS9 P Darvodelsky_V7.indd 101 3/10/18 5:22 pm
Testing secondary clarifiers to understand installed and theoretical capacity
Christie Cole
Increasing populations, ageing infrastructure and increased frequency and magnitude of rainfall events puts pressure on plant owners, managers and operators to achieve the required treatment capabilities under a range of increasingly difficult conditions.
In many cases, secondary clarification capacity is identified through theoretical calculations (and operational observations) as the limiting plant process. However, the full-scale installed secondary clarifier capacity is often very different in practice compared to the theoretical capacity and the limiting function/s are often unknown. Understanding the installed capacity and limitations of each clarifier enables the utility to fully use the asset, maintain licence compliance and accurately plan for future upgrades.
In design, a secondary clarifier’s calculated capacity is usually derated by a factor to account for full-scale nonidealities, termed the 'design factor'. Derivation of the installed design factor through in situ testing enables estimates of the true installed capacity based on
solids settling to be developed. Fullscale testing of secondary clarifiers was completed using the WERF Protocol for Evaluating Secondary Clarifier Performance (WERF/CTRC 2001). The project purpose was to understand the installed capacity as compared to the theoretical capacity of the secondary clarifiers and to identify the constraining elements of each secondary clarifier.
Identification of the limiting element of each clarifier enabled retrofits to be tailored with a focus on minimising the works required to maximise the installed capacity. This included investigation of the addition of polyelectrolyte to extend the clarifier capacity in certain situations (i.e. wet weather). A large range of installed to theoretical clarifier capacities was found, supporting the need to assess clarifiers in situ to understand their true capacity.
Polyelectrolyte was found to enhance the capacity in some (but not all) clarifiers tested, depending on the particular limitations. Other relatively minor retrofits, for example the installation of stamford baffles and adjustment of the launder configuration, were recommended to unlock latent capacities. While a reasonable investment in time and expenditure is involved in this form of testing, the outcomes in terms of plant improvements and savings in infrastructure investment are potentially significant, making the study a worthwhile exercise.
TO READ THE FULL ARTICLE visit the Water e-Journal at bit.ly/water_ejournal or scan the QR code
118 Ozwater'23 Discover more. awa.asn.au
Learning to identify and address any limitations of each secondary clarifier through full-scale testing.
“
A large range of installed to theoretical clarifier capacities was found, supporting the need to assess clarifiers in situ to understand their true capacity.

Technical Papers 119 Australian Water Association


Biofiltration’s effect on removing pollutants in stormwater
Over recent decades, the implementation of stormwater control measures (SCMs) to achieve a more water-sensitive urban environment and reduce the hydrologic and water quality impacts of urban development has increased across Australia and overseas (Ma et al, 2019; Hermawan et al, 2019; Dalrymple et al, 2018). Biofiltration systems (also called biofilters, bioretention basins, bioretention systems, bioswales and raingardens) are one of the most commonly used SCMs, given their flexible design, space efficiency and applicability at a variety of scales (Water by Design, 2014).

Filterra® biofiltration systems are similar to a typical biofiltration system. A key difference, however, is that Filterra® biofiltration systems use a filter media blend in a depth filter configuration that can treat flows at a significantly higher flow rate than typical biofiltration filter
media, which are configured as cake filters (Lenhart et al, 2015).
There are approximately 9000 Filterra® biofiltration systems in the USA and, while they have also been installed at locations in Australia, there has been a lack of treatment performance monitoring at a ‘real world’ site.
Stormwater treatment performance monitoring was undertaken for a high flow rate biofiltration system in Western Sydney. The system has a total area of 1.45m2 (0.34% of catchment) and 0.53m depth of Filterra® filter media, with a design treatment flow rate of 1.42 L/s, and receives runoff from a car-park area of 420m2.
Influent and effluent water quality samples were collected using automated samplers, which were connected to preconfigured and calibrated flow analysis of treated effluent and sample pacing (with remote communication and data access). Collected samples were delivered to and analysed in a NATA-accredited laboratory for pH and concentrations of suspended solids and nutrient species.
The biofiltration system was monitored between June 2019 and September 2020, with a total of 17 qualifying runoff events recorded during this period.
Results demonstrated that the high flow rate biofiltration system was able to achieve significant reductions in stormwater pollutant concentrations, with a concentration reduction efficiency ratio, for total suspended solids (81%), total phosphorus (83%) and total nitrogen (49%), after the 12-month establishment period.
121 Australian Water Association Technical Papers
The use of a biofiltration system in Western Sydney demonstrates effectiveness in removing solids and nutrients.
TO READ THE FULL ARTICLE visit the Water e-Journal at bit.ly/water_e_journal or scan the QR code
Brad Dalrymple, Michael Wicks, Warren Jones and Blake Allingham































Identifying alternative treatment options for removal of bushfire-related contaminants



Sydney Water’s treatability tests on Warragamba Dam successfully identified a two-stage pretreatment process to remove contaminants and supply safe drinking water.
Sydney’s Warragamba catchment was severely burnt by bushfires during a period of extreme drought in 2019. Sydney Water carried out extensive water quality analysis and treatability tests using bushfire ash from the catchment to determine the impact of bushfire ash on both raw water and drinking water quality and treatability. Water quality analysis showed a significant increase in turbidity, colour, organics, metals and nutrients in the ash-laden water. Extensive treatability tests successfully identified alternative treatment options for effective removal of these bushfire-related contaminants.
Following the bushfire, droughtbreaking heavy rainfall rapidly filled up Warragamba Dam and deteriorated the raw water quality as indicated by ash-laden water tests. Sydney Water’s extensive tests on water contaminated with bushfire ash provided early information on water quality and treatability impacts, which helped prepare risk management approaches for the drought-breaking rain event. Sydney Water continued to manage and treat poor-quality source water (and supply safe drinking water to customers) by comprehensive testing and optimisation at relevant water filtration plants.
TO READ THE FULL ARTICLE visit the Water e-Journal at bit.ly/water_e_journal or scan the QR code
Technical Papers 123 Australian Water Association
Mild-intensity burnt ash (top left) and high-intensity burnt ash (bottom left).
ASM Mohiuddin, Yue-cong Wang, Coralie Gabus and Phoebe Lingat


Is your pipe spacer compliant? Call us for details on ordering P (08) 9725 4678 sales@kwikzip.com www.kwikzip.com The only casing spacers successfully appraised by WSAA HDX and HDXT KWIK-ZIP’S HDX & HDXT CASING SPACERS COMPLY WITH WSAA PRODUCT SPEC #324 - CASING SPACERS; REFER WSAA PRODUCT APPRAISAL REPORT #1523
New guidance values for chlorine in marine waters









 Dr Ian Wallis and Scott Chidgey
Dr Ian Wallis and Scott Chidgey
Seawater is used for a range of activities along the coast and at sea, including cooling water for power stations and ship engines, industrial processes and in desalination plants. Chlorine is often used in these systems to prevent the settling and growth of marine organisms in the pipes and heat exchangers, so discharge of chlorinated water to the marine environment is common globally.

A water quality limit for chlorine is required to ensure these discharges don't adversely impact the marine environment. Most countries have a water quality limit, or guideline value, and usually the limit for marine waters is higher than for freshwater.
Chlorine decays rapidly in seawater. Field experiments carried out to measure the rate of decay of chlorine found that an initial chlorine concentration of 0.5 to 0.6 mg/L reduced to less than 0.1 mg/L in an hour. A higher initial chlorine concentration of 1.41 mg/L decayed by 50% in about half an hour and by 90% in two hours. Over all four tests, the decay rate was faster than 50% per hour. Because of this high decay rate, it

is impractical to carry out single-dose toxicity tests for chlorine in seawater as the chlorine will progressively decrease over the duration of a 4-hour test and will be negligible after a 24 hour test. Instead, flow-through toxicity tests must be used.


A species sensitivity distribution was developed using toxicity tests on 30 species from nine taxonomic groups. The results of a recent sea urchin fertilisation test in Sydney were included, replacing the 1981 sea urchin tests in Canada. Using an application factor of two, the resulting new guideline values for chlorine are:
• CPO of 12 µg/L for 99% species protection
• CPO of 18 µg/L for 95% species protection












The guideline values for chlorine are consistent with field observations of substantial numbers of sea urchins thriving in Corio Bay in a habitat exposed to consistent CPO concentrations of 5 to 10 µg/L, which were previously thought to be sensitive to chlorine at 5 to 6 µg/L, although the recent Sydney tests show this is not the case.

Technical Papers 125 Australian Water Association
Using flow-through toxicity tests instead of single-dose toxicity tests to accurately ensure chlorine discharge does not adversely impact the marine environment.
TO READ THE FULL ARTICLE visit the Water e-Journal at bit.ly/water_ejournal or scan the QR code
Our HPL culverts are setting new standards and proving a very cost-effective alternative to pre-cast concrete.













Roundel’s HPL PE-coated steel culverts offer significantly improved durability performance compared to traditional Z600 galvanised steel.
HPL is fully compliant with AS / NZS 2041.4, ASTM A742, and has been extensively tested locally to demonstrate a 100-year life, with exceptional abrasion performance. It is available for internal and / or external surfaces depending on your requirements.
The coating’s superior performance has been widely recognised by the major mining companies, nation-wide State Departments such as MRWA, TMR, DELWP and ARTC.






Roundel welcomes your inquiries for HPL-coated culverts, traditional Z600 galvanised culverts and our wide range of B200 and B381 bolted, corrugated steel structures.

ENQUIRIES WA 08 9404 5391 QLD 07 4789 6700 General 1800 194 746 roundel.com.au









YOUR PIPELINE PARTNER OF CHOICE Iplex is proud to work closely with industry partners to help solve Australia’s water challenges MARKETS WE SERVE CIVIL INFRASTRUCTURE TRENCHLESS IRRIGATION PLUMBING Ready to learn more? Visit our stand at Ozwater’23 (L26) to speak with our sales team about your water project needs. CIVIL 13 10 86 MERCHANTS 1300 047 539 IPLEX.COM.AU IPLEX PIPELINES
Smooth optimisation of demand patterns in a water distribution system hydraulic model
The demand multipliers in a real water distribution system (WDS) don't sharply rise or fall between two adjacent timestamps. Rather, they change in a regular fashion. Hence using different methods, including pre-smoothing them before populating the model input file or expressing them as a function of time and optimising the function parameters, allows representing the pattern between two adjacent timestamps more practically. Therefore, the objectives of this study are: to assess and incorporate the smoothness option into the calibration process; and to calibrate the hydraulic model while maintaining the maximum smoothness of the demand patterns. It proposes a new approach to obtain smooth demand patterns, while calibrating WDS hydraulic models using an automatic calibration method. The water usage patterns in a WDS vary throughout the day and night, which is represented by demand
multipliers. Through the calibration process, many parameters, including demand multipliers, are adjusted to minimise the difference between the simulated and observed data at the point of interest. This is achieved by minimising the objective function value.
The demand multipliers in a 24-hour cycle sometimes become precipitous, and often a major difference between two adjacent demand multipliers is observed due to under or over-calibration that is unrealistic. To obtain a smooth demand pattern, programming functions were incorporated with the calibration process. Two different approaches were investigated. In the first approach, the demand multipliers as sampled by the optimisation algorithm within their specified range, were smoothed by a smoothing function and used the smoothed pattern in assessing the objective function value. In the second approach, the demand pattern was represented by a Fourier polynomials function to optimise the function parameters. The proposed method tries to keep a balance between minimum objective function and the smoothness of demand patterns. This approach was applied in calibrating the hydraulic model of a large WDS in South Australia and was found to have the potential to ensure minimum objective function as well as smoothness of demand patterns. This method is suitable when there is insufficient field data available to create demand patterns, rather than estimating them through model calibration.

Technical Papers 129 Australian Water Association TO READ THE FULL ARTICLE visit the Water e-Journal at bit.ly/water_e_journal or
the QR code
scan
How an automated calibration method can achieve smoother demand patterns in water distribution system hydraulic models.
Sharif Hossain, Guna Hewa, Christopher Chow and David Cook
WATER E-JOURNAL STUDENT EDITION
The Australian Water Association’s inaugural Water e-Journal Student Edition was launched in 2022, featuring an array of outstanding technical papers produced by students across Australia. Here's the full list of published papers.
An eco-geomorphological modelling framework for vulnerability assessment of coastal wetlands
Angelo Breda Sr.
Application of high-frequency, real-time data for a fertiliser management decisionsupport system
Martin Jason Luna Juncal
Colloidal silica and silica-rich nanoparticles through stages of reverse osmosis treating coal seam gas associated water: occurrence, evolution and speciation
Esmaeil Sarabian
Comparison of chlorine and ultraviolet disinfection processes for wastewater treatment
Ryan Smith
Developing a peaks-over-threshold based flow estimation method
Xiao Pan
Developing electrochemical sensors for real-time analysis of inorganic nitrogen in water
Fiona Jing Fang Tan
Development of a sustainable automatic disinfection system for rainwater treatment
Sajeeve Latif I
Development of new regional flood estimation methods for New South Wales
Ayesha Rahman
Development of strategies to reduce, remove and recover microplastics from the whole of water supply cycle
Kala Senathirajah
Drought modelling and evaluation in south-east Australia
Gokhan Yildirim
Effectiveness of rainwater harvesting systems for Australian capital cities
Preeti Preeti
Effects of in-sewer processes on the fate of coronavirus in wastewater
Ying Guo
Enhanced stormwater treatment performance by design modifications to the permeable pavement structure
Upeka Kuruppu
Enhancing integrated DAMO-Anammox processes for nitrogen and methane removal
Yan Chen
Enhancing wastewater-based epidemiology of pathogenic Campylobacter
Shuxin Zhang
Greater Hobart chlorine control review
Riley Jaack Murtagh-Linnell
Identification of homogeneous regions in regional flood frequency analysis under changing climate
Ali Ahmed I
Impacts of climate change on temperature in New South Wales, Australia
Orpita Urmi Laz
Investigation of the presence and control of cyanobacteria in paper mill wastewaters
Hugh Burger
Managing the risk of Legionella in drinking water treatment aeration systems
Danladi Yunana
Non-stationary flood frequency analysis in Australia
S M Anwar Hossain
Online water quality monitoring and process control using UV-vis sensors
Linda Shi
Post-processing sub-seasonal to seasonal climate forecasts under climate change
Yawen Shao
Regional flood frequency analysis in Australia using generalised extreme value distribution
Laura Rima
Regional flood frequency analysis using linear and non-linear techniques
Amir Zalnezhad
Religious motivations to preserve water: an Islamic perspective
Mohammad Abu Hurayra
Solution to drinking water supply for rural community based on rainwater harvesting
Que Thanh Trinh
Use of microalgae for treating municipal wastewater reverse osmosis concentrate and resource recovery
Arash Mohseni
130 Technical Papers TO
e-Journal
bit.ly/water_ejournal
Ozwater'23 Discover more. awa.asn.au
READ THE FULL ARTICLE visit the Water
at
or scan the QR code
TO READ THE FULL 2023 WATER E-JOURNAL STUDENT EDITION scan the QR code
YOUR PARTNER TO NET ZERO
TURN YOUR WASTEWATER TO ENERGY


Reach your net zero emission target by partnering with Evo Energy Technologies

We can help you achieve a sustainable waste-to-energy solution and reduce your operating costs and dependence on electricity from the grid. Speak to us today about our superior technology that will help you fast track minimising your carbon emission goal.
BIOGAS, NATURAL GAS & HYDROGEN GAS COGENERATION • BIOMETHANE PLANTS








2022 GERMANY COGENERATION & RENEWABLE GASES TOUR
Don’t miss this rare opportunity!
We are pleased to announce our 2022 Factory Visit and Site Tours in conjunction with our technology partners 2G Energietechnik, ETW Energietechnik and Sattler in Germany. This rare opportunity will take you behind-the-scenes at some of the world’s leading cogeneration and renewable gases companies, where you will see their equipment in action at installation sites.
Commencing 6th June 2022, this tour will coincide with IFAT - the world’s leading trade fair for water, sewage, waste and raw materials management.
YOUR PARTNER TO NET ZERO

evoet.com.au | 1300 859 933
ROM E INFO
Current Magazine.indd 1 18/03/2022 9:42:32 AM
WE SOLVE YOUR WATER CHALLENGES


LEADERSHIP IN GLOBAL WATER TECHNOLOGY



We are a global team unified in a common purpose: creating advanced technology solutions to the world’s water challenges. Developing new technologies that will improve the way water is used, conserved, and re-used in the future is central to our work. Our products and services move, treat, analyse, monitor, and return water to the environment in the mining, industrial, public utiltity, residential, and commercial building services sectors. We also provide a leading portfolio of smart metering, network technologies, and advanced analytics solutions.
SALES - SERVICE - RENTAL








13 19 14 | solve@xylem.com | xylem.com/au
@xylemanz
















































 A product development by
A product development by































































 By Cecilia Harris
By Cecilia Harris























 By Chris Sheedy
By Chris Sheedy




























 An almost empty farm dam in rural Australia, cracked and eroded from years of drought followed by heavy rains.
A large agricultural irrigation dam turned to salt due to drought in Australia.
An almost empty farm dam in rural Australia, cracked and eroded from years of drought followed by heavy rains.
A large agricultural irrigation dam turned to salt due to drought in Australia.

































































 to
to



 By Elle Hardy
By Elle Hardy
























































 By Martin Kovacs
By Martin Kovacs




















 Q&A: MARLENE KANGA Dr Marlene Kanga discusses why intersectional diversity is crucial.
Q&A: MARLENE KANGA Dr Marlene Kanga discusses why intersectional diversity is crucial.























































 By Cecilia Harris
By Cecilia Harris

























 By Martin Kovacs
By Martin Kovacs






 Luc Turner is the Water & Wastewater Industry Manager at Endress+Hauser Australia.
Luc Turner - Endress+Hauser Australia
Luc Turner is the Water & Wastewater Industry Manager at Endress+Hauser Australia.
Luc Turner - Endress+Hauser Australia































































 By Elle Hardy
By Elle Hardy

Dr Ian Wallis and Scott Chidgey
Dr Ian Wallis and Scott Chidgey






















































